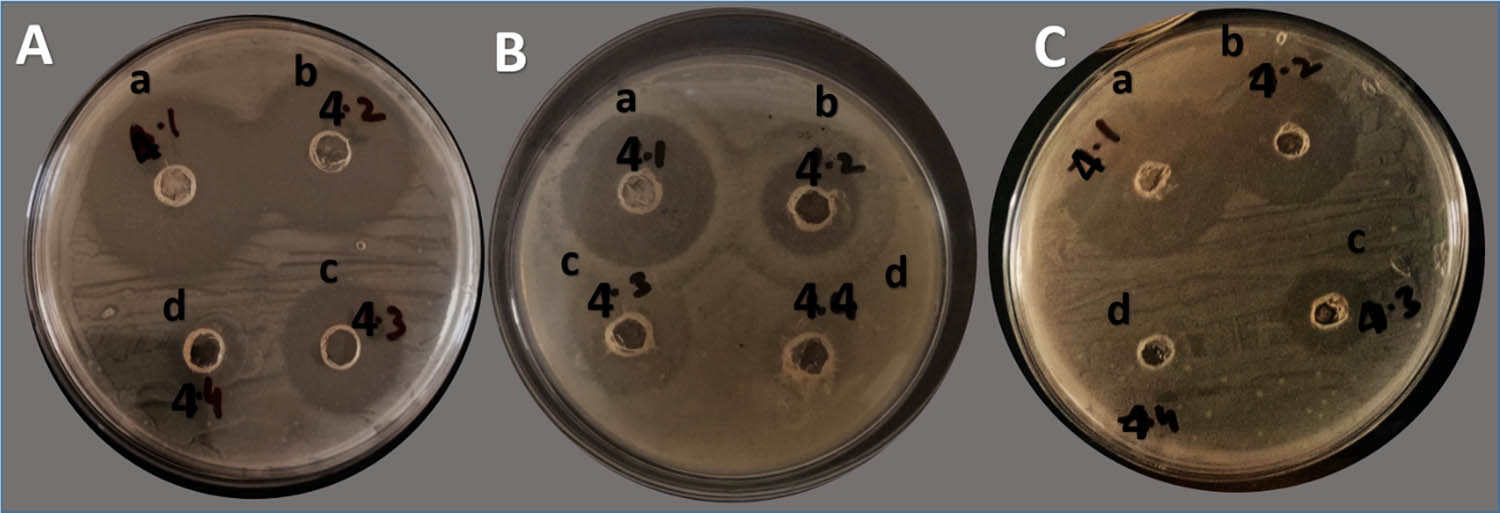

Abstract
Metallic nanoparticles exist in significant diversity in structure and function with particular context to the safer use in biological sciences. The antibacterial properties of nanoparticles are attributed to the mechanisms, including but not limited to the generation of reactive oxygen species, direct damage to the cellular contents, disrupting cell wall integrity, and inhibiting efflux pumps. These mechanisms along with those of the antibiotics may potentiate resistance modulation of pathogenic bacteria. This study aimed to evaluate tungsten oxide (WO3) nanoparticle-coupled antibiotics for their structural and functional characteristics, safety profile in terms of genotoxicity, and antibacterial potential against drug resistant S. aureus and E. coli of Houbara bustard birds. The WO3 nanoparticles were prepared by hydrothermal method while antibiotics were coupled by the chemical reduction method furnishing seven treatments as non-coupled tungsten oxide (WO3) nanoparticles (W), and WO3 nanoparticle-coupled with; ciprofloxacin (CW), oxytetracycline (OW), ampicillin (AW), ciprofloxacin+ penicillin (CPW), oxytetracycline+ penicillin (OPW), and ampicillin+ ciprofloxacin (ACW). X-ray diffraction studies indicated that WO3 was highly crystalline, and FTIR confirmed the presence of functional groups like W═O, O–W–O, and W–O–O–W, validating the successful synthesis of WO3 nanoparticles through hydrothermal method. Phenotypic antibacterial expression in terms of zone of inhibition of treatments at 100 and 10 µg/mL was found to be higher in the case of AW and CW, respectively, against E. coli; CW and ACW against S. aureus; and CW at both concentrations against the mixed bacterial culture of S. aureus and E coli. Minimum inhibitory concentration (MIC) against both S. aureus and E. coli, in case of CW, was found to be 20.84 ± 8.07 µg/mL, while AW showed 26.04 ± 9.02 µg/mL against mixed bacterial culture. Safety profiles of nanoparticle-coupled antibiotics, on the other hand, revealed moderate to lower genotoxicity in the form of DNA damage on onion cells in dose and time-dependent manner. The study thus concluded that tungsten oxide nanoparticle-coupled antibiotics were potential antibacterial candidates against enteric pathogens of Houbara bustard birds but requires careful dose optimization as a crucial step for biosafety profiles of WO3-based therapeutic formulations.
Graphical abstract

Abbreviations
- ACW
-
ampicillin+ ciprofloxacin+ WO3 nanoparticles
- AMR
-
antimicrobial resistance
- ARGs
-
antibiotic-resistant genes
- AW
-
ampicillin+ WO3 nanoparticles
- CPW
-
ciprofloxacin+ penicillin+ WO3 nanoparticles
- CTAB
-
cationic surfactant cetyl-trimethyl ammonium bromide
- CW
-
ciprofloxacin+ WO3 nanoparticles
- NPs
-
nanoparticles
- OPW
-
oxytetracycline+ penicillin+ WO3 nanoparticles
- OW
-
oxytetracycline+ WO3 nanoparticles
- ROS
-
reactive oxygen species
- SEM
-
scanning electron microscopy
- W
-
tungsten oxide nanoparticles
1 Introduction
The unique physicochemical characteristics of metallic nanoparticles (MTNPs), such as their high surface area to volume ratio, variable surface chemistry, ability to generate reactive oxygen species (ROS), and potential to overcome antibiotic resistance, have made them a promising candidate in the field of antimicrobial research. MTNPs can disrupt bacterial cell membranes through direct physical contact, which can cause structural damage and ultimately the release of intracellular components [1]. The antibacterial properties of metals and metallic oxides, such as silver, gold, copper, and zinc oxide, have been demonstrated to inhibit the growth of many bacteria. The mechanism of the antibacterial effect of NPs is determined by their size, shape, concentration, and interaction with the target microbes [2]. These nanoparticles work in a variety of ways because of their small size, which increases their surface area and promotes contact with bacterial membranes. They also interfere with metabolic pathways and inhibit efflux pumps, which hinders bacterial metabolism, stops biofilm formation, and increases antimicrobial activity. Silver, zinc, and tungsten-based metal nanoparticles (NPs) have demonstrated encouraging synergistic interactions with traditional antibiotics, perhaps reversing resistance phenotypes and improving therapeutic efficacy [3,4]. This strategy prevents bacteria from becoming resistant, which overcomes a basic challenge with conventional antibiotics [5]. In medicinal applications, MTNPs have been known to exhibit unavoidable roles [6] in medicine delivery, immunoassay, pharmacy, and polynucleotide detection by suppressing both Gram-positive and Gram-negative bacteria [7].
Tungsten-based nanoparticles among various MTNPs are considered appropriate for a combination therapeutic strategy due to their multi-targeting properties [8,9]. Tungsten-based nanoparticles are excellent at preventing bacterial growth and encouraging bacterial cell death because they work through a variety of pathways [10]. These nanoparticles have the potential to improve the efficacy of treatments, avoid resistance, and possibly lower the dosage of individual drugs by focusing on distinct cellular routes or activities in combination with other antibiotics. Antibiotics can be more precisely delivered to bacterial cells by using the nanoparticles as carriers or delivery systems. The stability and bioavailability of antibiotics can be enhanced by the nanoparticles, which will increase their overall anti-bacterial effectiveness by preventing degradation and raising their concentration at the infection site [11].
This is imperative to focus on alternative antimicrobials that can hinder the spread of antibiotic resistance. It becomes more important in case the antibiotic resistance genes and multidrug-resistant bacteria become a threat to public and animal health [12]. It is possible that migratory birds may transport and disperse some highly pathogenic microorganisms because they usually fly considerable distances in response to large-scale seasonal climate variation [13]. These migratory bird-borne bacteria were found in the intestines of avian species as part of infectious microorganisms [14]. One of such bird is the Houbara bustard which is among the threatened species with respective to conservation, however, research is meager than needed when it comes to enteric pathogens. Moreover, the one health concern bacteria includes E. coli and S. aureus, which require more attention due to their multidrug-resistance and dissemination potential.
It is equally important to know cellular toxicity while targeting bacterial pathogens in the host. There have also been attempts to reduce the toxicity by changing the size of tungsten oxide nanoparticles [15]. Through their interactions with the components of the cell wall and membrane, nanoparticles larger than 10 nm have the potential to produce cytotoxicity and cellular disintegration [16]. However, smaller nanoparticles might also exhibit their considerable adverse effects [17]. In addition to size, there are a number of structural aspects of nanoparticles that may result in toxicity and hence requires that toxicity analysis be done in parallel. Hence, according to the current scenario, nanoparticles prove to be promising antibacterial candidates that may fill in the gaps created by antibiotics [18]. The current study was thus aimed to explore insights into the structural profile of tungsten oxide nanoparticle-coupled antibiotics, evaluation of these treatments against bacterial strains (both individual culture and mixed cultures of S. aureus and E. coli) isolated from Houbara bustard birds, and estimation of genotoxicity as proof of safety profile adhered to the prepared treatments.
2 Materials and methods
2.1 Preparation of nanoparticles
Tungsten oxide (WO3) nanoparticles were prepared by the hydrothermal method. In two separate flasks, 1.4 g of cationic surfactant cetyl-trimethyl ammonium bromide (CTAB) (99.99% pure) was dissolved in 18 mL of distilled water, while 6 g of sodium tungstate dehydrate (99.99%) was mixed in 36 mL of distilled water. Under constant magnetic stirring, CTAB was dropwise added to an aqueous solution of sodium tungstate. The pH was maintained at 2–3 by using 1 M HCl. For a slow but progressive reaction, the precursor was transferred to a stainless-steel autoclave for hydrothermal treatment for 4 days at 80°C. By washing 4–5 times with distilled water, the precipitates were recovered by repeated centrifugation. The precipitates were subjected to oven drying at 120°C for 3 h, and each product was calcined at 500°C to obtain the pure crystalline WO3 nanoparticles [19].
2.2 Coating WO3 nanoparticles with antibiotics
Antibiotics were attached to nanoparticles using the chemical reduction method. About 20 mL of deionized water was used to dissolve 0.035 g of the drug (ciprofloxacin, ampicillin, oxytetracycline, and penicillin) at room temperature. Then, 1.5 g of nanoparticles was added to the mixture and agitated for 5 h, while polyvinyl propyl was present. For 24 h, the solutions were kept at room temperature while being constantly stirred and mixed. To allow the product to settle to the bottom, it was centrifuged for 30 min at 3,000 rpm. The product was dried at 100°C for 8 h before being ground with a mortar and pestle [20]. The final products obtained were ciprofloxacin + WO3 nanoparticles (CW), ampicillin + WO3 nanoparticles (AW), oxytetracycline + WO3 nanoparticles (OW), WO3 nanoparticles (W), ciprofloxacin + penicillin + WO3 nanoparticles (CPW), oxytetracycline + penicillin + WO3 nanoparticles (OPW), and ampicillin + ciprofloxacin + WO3 nanoparticles (ACW).
2.3 Characterization of WO3 nanoparticles
X-ray diffraction (XRD) was utilized to determine the crystallinity of the nanoparticles using a powder diffractometer (Rigaku D/max Ultima III). A Cu-Kα radiation source with a wavelength of 0.15406 nm was used to operate it at 40 kV and 0.130 A current; the 2θ values were between 20° and 80°. For scanning electron microscopy (SEM) of images, Quanta 250 (30 kV) was used, and for characterization assessment, Fourier-transform infrared spectroscopy (FTIR) was performed in the 4,000–5,000 cm−1 wavenumber range [21].
2.4 Antibacterial potential of nanoparticle-coupled antibiotics
2.4.1 Bacterial selection
Nanoparticle-coupled antibiotics were applied to Staphylococcus aureus (S. aureus) and Escherichia coli (E. coli) isolated from cloacal samples of Houbara bustard birds. The institutional Review Board (IRB), Office of Research Innovation & Commercialization (216/ORIC/GSCWU/2025) of Government Sadiq College Women University Bahawalpur approved ethical aspects of current study. The swab samples (n = 200) collected from Houbara bustard birds were subjected to microbiological and biochemical processes for isolation, identification, and characterization of S. aureus and E. coli, keeping in view the guidelines of Bergey’s manual of determinative bacteriology [22]. Polymerase chain reaction was also carried out for further confirmation of the pathogens before subjecting them to susceptibility trials. The bacterial isolates resistant to oxytetracyline, ampicillin, penicillin, and ciprofloxacin were selected for susceptibility trial against nanoparticle-coupled antibiotics. The susceptibility trial thus consisted of n = 06 S. aureus and n = 06 E. coli resistant to antibiotics coupled with tungsten oxide nanoparticles in order to evaluate the resistance modulation potential of nanoparticle-coupled antibiotics.
2.4.2 Preparation of bacterial cultures
Three types of bacterial preparations were made: (a) individual culture E. coli, (b) individual culture S. aureus, and (c) a mixed culture of both S. aureus and E. coli. For the well diffusion assay, fresh growth of both bacteria (a, b) was adjusted to 0.5 McFarland (1–1.5 × 108 CFU/mL). However, for mixed bacterial culture (c), half the volume from both of the individual bacterial cultures adjusted at 0.5 McFarland was taken into a tube, making all the three bacterial preparations (a, b, c) at equal concentration equivalent to 0.5 MacFarland). For the broth micro-dilution assay, the same protocol was applied, but the concentration of bacteria was diluted to 1–1.5 × 105 CFU/mL as per the guidelines of Clinical Laboratory and Standards Institute.
2.4.3 Susceptibility protocols
The antibacterial potential of the nanoparticle-coupled antibiotics was evaluated by the well diffusion method, while minimum inhibitory concentration (MIC) was calculated using the broth micro-dilution method on individual bacterial culture and mixed bacterial culture.
Briefly, for the well diffusion assay, 6–8 mm diameter wells were prepared on sterilized Mueller–Hinton agar plates. Nanoparticle-coupled antibiotics at concentrations of 1,000, 100, and 10 µg/mL were added to the wells after swabbing of bacteria. These plates were incubated for 24 h at 37°C, as described in the study of Anwar et al. [20]. The zones around the wells were measured using vernier calipers. In order to measure the MIC of nanoparticle-coupled antibiotics against individual bacterial culture and mixed bacterial culture, sterile nutrient broth was transferred to a 96-well titration plate. The preparations starting from 1,000 µg/mL were poured using two-fold dilutions (comprising a range of 1,000–0.97 µg/mL) until the 11th column, while the last column was left with only broth or bacterial suspension in the broth. In all wells, standard bacterial suspension (1–1.5 × 105 CFU/mL) was poured in all wells, except the negative control (only broth). The OD value of titration plates at 600 nm wavelength was measured before incubation and after incubation at 37°C for 24 h. MIC was measured as the lowest concentration able to inhibit the growth of bacteria.
2.5 Toxicity analysis of nanoparticle-coupled antibiotics
Toxicity analysis of nanoparticle-coupled antibiotics was carried out on onion by isolating the nucleus from onion roots using 600 µL of isolation buffer. This buffer was prepared by mixing 4 mM MgCl2·H2O, 0.5% W/V Triton X-100, and 200 mM Tris in a beaker. The pH of the buffer was maintained at 7.5. After that, it was stored in a test tube and wrapped with aluminum foil. Normal-melting-point agarose (NMPA) was taken in a test tube, and 1 mL of IX phosphate buffer saline (PBS) was added using a pipette. The test tube, held using a test tube holder, was heated on a Bunsen burner until NMPA was completely dissolved in PBS. Then, 0.001 g of low-melting-point agarose (LMPA) was weighed on a weighing balance. LMPA (1.5%) was dissolved in 1,000 µL of IX PBS by constantly heating on a burner and shaking the test tube for complete dissolution. Modifications to the comet assay revealed that antibiotics coated with nanoparticles caused DNA damage in onion root cells [23]. To produce the roots, onions were grown in distilled water for 2–3 days at room temperature in the dark. Onions were treated with test concentrations of antibiotics coated with nanoparticles at 10, 1, 0.5, and 0.025 mg/mL. Distilled water served as the negative control, while MMS (10 mg/mL) served as the positive control. Using nucleus isolation buffer (4 mM MgCl2·6H2O, 0.5% w/v Triton X-100, and 200 mM Tris, at pH 7.5), sliced root tips were crushed in a Petri dish on an ice box on the day of the experiment in order to extract DNA, and the suspension was run through a nylon filter.
The extracted DNA was centrifuged for 7 min at 4°C at 12,000 rpm, and the supernatant was removed. PBS was used to prepare LMPA. About 1% NMPA was used to pre-coat the slides. Following centrifugation, a pellet was produced, and 1.5% LMPA (1:1) was pipetted onto slides that had already been coated. When spreading the nuclei or DNA across the slides, gel was utilized to keep them in place [24]. After covering them with cover slips, the slides were placed in an ice box and left for 5 min. Slides were submerged in cooled electrophoresis buffer containing 300 mM NaOH and 1 mM EDTA for 20 min prior to electrophoresis after the cover slips were removed to unwind the DNA sample [25]. At 25 V and 300 mA, electrophoresis was run for 20 min. After electrophoresis, the slides were neutralized using Tris buffer which included 400 mM trizma base at pH 7.5. To view the comet tail under a fluorescence microscope, the slides were treated with ethidium bromide and exposed to the dark for 5 min. Based on the degree of DNA damage, cells were assigned a score ranging from 0 (no harm) to 4 (highest level of damage). To prevent bias, three slides were made for each concentration, and 50 cells were counted from each plate.
2.6 Statistical analysis
The data obtained in the current study were mainly quantitative, consisting of more than two groups for which Analysis of Variance (ANOVA) was applied. Further, a comparison of the means was done to determine the difference of significance among different groups at 5% probability. Toxicity analysis was performed by assigning the arbitrary unit of measurement to express the extent of DNA damage. For this, the following formula was applied:
where n i is the number of cells assigned a score of i and i represents the comet class (0 = no damage, 4 = maximum damage).
3 Results
3.1 XRD analysis of WO3 nanoparticles
XRD was used to investigate the crystalline structure of pure WO3 plotted between 2θ (°) values and the intensity of the synthesized products, as shown in Figure 1. The strong Bragg reflection at 2θ values of 23.52°, 24.23°, 28.56°, 33.97°, 38.35°, 41.79°, 44.70°, 47.35°, 50.22°, 56.20°, 58.87°, 65.09°, and 78.30° were observed corresponding to the Miller indices of (001), (200), (111), (021), (131), (221), (321), (040), (400), (401), (331), (510), and (160), respectively (PDF # 96-101-0619). It is clear from the WO3 XRD patterns (Figure 1) that the peaks recorded at 2θ value of 65.09° were indexed to the (102) plane. The crystal lattice had a triclinic unit cell phase and lies in the P-1 (2) space group. Its mineral name is tungsten trioxide. The standard cell lattice parameters of WO3 were a = 7.28000 Å, b = 7.48000 Å, c = 3.82000 Å, α = 3.82000° Å, β = 90.000°, and γ = 90.000°. The peaks at 58.90 and 65.09 corresponded to the W-metallic phase, respectively. All the peaks indicate that the product was highly crystalline. Furthermore, some extra peaks were also observed due to the carbon–carbon-related phase observed during the calcination process when CTAB was removed. Here, the CTAB solution employed at room temperature resulted in a triclinic crystal phase of WO3, demonstrating that surfactants in the solution control the crystal development. The WO3 triclinic phase reflection is the source of these peaks. When surfactants were added, the XRD peak intensity dropped, suggesting that the surfactants had an impact on the WO3 nanoparticles' crystallinity.

XRD pattern of the synthesized WO3 nanoparticles.
3.2 SEM visualization of antibiotic-coupled WO3 nanoparticles
Figure 2 displays the SEM images of the antibiotic-coated WO3 product, which was produced using the chemical reduction and hydrothermal methods. SEM shows detail of the product’s exterior morphology. Figure 2 shows a broad perspective of the WO3 nanoparticle, whereas Figure 2(a)–(f) displays higher resolution pictures that reveal more specific morphological characteristics. Figure 2a indicates that the produced WO3 nanoparticles were nanometer-sized with the surface appearing smooth upon closer inspection and having an oval or spheroidal shape. Additionally, the images demonstrate that only a small number of spherically shaped nanoparticles are generated. While some nanoparticles exhibit aggregation, others are well separated. Irregular forms were also detected in these particles. Smaller particles adhere to a range of particle sizes to form aggregates. A comprehensive view of the coated particles at various magnifications is shown in Figure 2(b)–(f). The coated product’s morphology also showed that the particles were oval-like and spheroidal in shape, with distinct boundaries connected to each other. This was caused by tungsten, which envelops the nucleus particles and absorbs on the surface of the drug particles. Tiny particles are created when nuclei come together. Additionally, a complex was created when tungsten coordinated with drug molecules in W+6 and O−2. The synthesis on the surface of the nanoparticles was responsible for the further particle development, and WO3 was readily coordinated with OH− and only weakly soluble in water.

SEM analysis of the synthesized WO3 nanoparticles: (a) WO3 nanoparticles prepared by the hydrothermal method, and (b)–(f) WO3-coated with antibiotics by the chemical reduction method.
The average WO3 particle size was determined to be approximately 27.5 nm. The size distribution of the spherical and spheroid-shaped WO3 nanoparticles is depicted by the histogram in Figure 3, which shows an average particle size of about 27.5 nm with a rather wide standard deviation of ±20.90 nm. With the mode, which represents the most common size range, ranging between 30 and 40 nm, the distribution shows a significant percentage of nanoparticles deviating from the mean. To represent the central tendency of the datasets, the median particle size was determined to be 55 nm. The histogram in Figure 3, on the other hand, shows a noticeable decrease in the particle size after the coating procedure, with an average size of around 27.5 nm. Several mechanistic aspects contribute to the coated product’s smaller average size when compared to the original WO3 nanoparticles. The nucleating drug particles are mostly surrounded by tungsten species, which adsorb onto their surfaces and prevent widespread particle development. Consequently, nuclei unite and transform into more compact and stable particles. Additionally, stable coordination complexes are formed when tungsten ions (W6⁺) coordinate with oxide (O2⁻) ions and the functional groups of the drug molecules. WO3 easily interacts with hydroxide ions (OH⁻) because of its low solubility in aqueous environments, which promotes surface complexation and passivation. The production of uniformly dispersed, nanoscale particles is the outcome of this coordination and surface contact, which prevents further crystallite development.

Size distribution of WO3 nanoparticles.
3.3 FTIR analysis of pure WO3
The FTIR spectrum of pure WO3 nanoparticles (Figure 4) shows characteristic bands at 3,600, 3,040, 1,720, 1,470, and 734 cm−1. The band at 3,481 cm−1 corresponds to O–H stretching, indicating adsorbed water or hydrated WO3. The 3,080 cm−1 band is attributed to C–CH3 and N–CH3 vibrations from CTAB surfactants. The 1,649 cm−1 band arises from O–H bending, suggesting surface water without bulk incorporation. The 1,435 cm−1 band is due to methylene and methyl group deformation in CTAB. The 799 cm−1 band indicates W–O–W stretching, confirming WO3 formation. The FTIR spectra confirm the presence of functional groups like W═O, O–W–O, and W–O–O–W, validating the successful synthesis of WO3 nanoparticles via should be in non-italic form the hydrothermal method.

FTIR spectra of the WO3 nanoparticles by the hydrothermal method.
3.4 In vitro antibacterial activity of nanoparticle-coupled antibiotics
3.4.1 Phenotypic expressions of treatments
Phenotypic expression of nanoparticle-coupled antibiotics was measured in the form of a visible zone of inhibition (ZOI) (Figure 5) around the wells. Two types of analyses were made: (a) comparison of ZOI among the nanoparticles at each concentration against each of the bacterial culture type (Table 1) and (b) comparison of ZOI among different concentrations of treatments (1,000, 100, and 10 µg/mL) for each type of treatment for each bacterial culture type (Figure 6).
Bacterial ZOI (mm) at different concentrations by well diffusion. A = S. aureus; B = E. coli; C = mixed bacteria: (a) 1,000 µg/mL; (b) 100 µg/mL, (c) 10 µg/mL, and (d) 1 µg/mL; no zones were reported. The black writing on plates other than alphabets were for researcher's identity marks and these are not related to antibacterial activity or anything like that.
ZOI values of individual and mixed bacterial cultures against nanoparticle-coupled antibiotics at different concentrations
| Bacterial culture type | Treatment groups | ZOI (mm) at different concentrations of nanoparticle-coupled antibiotics | ||
|---|---|---|---|---|
| 1,000 µg/mL | 100 µg/mL | 10 µg/mL | ||
| Individual culture of S. aureus | CW | 31.00 ± 4.55A | 24.75 ± 6.34A | 19.00 ± 6.22A |
| AW | 25.00 ± 3.46ABC | 16.25 ± 1.500B | 10.500 ± 1.29B | |
| OW | 28.00 ± 1.83AB | 22.00 ± 1.826AB | 12.750 ± 0.95AB | |
| W | 20.75 ± 2.06C | 15.50 ± 2.08B | 9.500 ± 0.57B | |
| CPW | 23.750 ± 1.70BC | 17.00 ± 2.45B | 11.00 ± 2.45B | |
| OPW | 25.75 ± 3.30ABC | 14.75 ± 2.75B | 10.250 ± 1.50B | |
| ACW | 30.25 ± 3.86AB | 22.25 ± 3.69AB | 14.25 ± 2.22AB | |
| Individual culture of E. coli | CW | 22.50 ± 1.73AB | 14.75 ± 1.258AB | 11.500 ± 1.000A |
| AW | 22.00 ± 1.633AB | 16.00 ± 2.16A | 10.000 ± 0.81AB | |
| OW | 23.75 ± 0.957A | 15.75 ± 2.22A | 9.500 ± 0.57B | |
| W | 14.50 ± 0.577E | 11.50 ± 0.57B | 7.500 ± 0.57C | |
| CPW | 19.75 ± 1.258BC | 15.50 ± 2.08A | 10.750 ± 0.95AB | |
| OPW | 16.00 ± 1.155DE | 13.00 ± 0.81AB | 9.250 ± 0.50BC | |
| ACW | 18.00 ± 1.633CD | 14.250 ± 0.957AB | 10.500 ± 1.000AB | |
| Mixed culture of E. coli + S. aureus | CW | 31.33 ± 1.528A | 19.00 ± 2.65A | 12.333 ± 0.577A |
| AW | 18.33 ± 0.577CD | 14.00 ± 1.000BC | 8.000 ± 1.000B | |
| OW | 19.33 ± 1.155C | 14.333 ± 0.577BC | 9.667 ± 1.528AB | |
| W | 16.33 ± 0.577D | 11.667 ± 0.577C | 8.333 ± 0.577B | |
| CPW | 25.33 ± 1.155B | 16.333 ± 1.155AB | 9.333 ± 1.528AB | |
| OPW | 20.33 ± 0.577C | 15.00 ± 1.73ABC | 9.333 ± 1.155AB | |
| ACW | 23.67 ± 0.577B | 16.00 ± 2.00ABC | 10.333 ± 1.155AB | |
Different superscripts (capital alphabets) within columns indicate significant differences among different treatments at each concentration against S. aureus. The same holds for E. coli and mixed culture (S. aureus + E. coli) tungsten oxide nanoparticle-coupled ciprofloxacin (CW); tungsten oxide nanoparticle-coupled ampicillin (AW); tungsten oxide nanoparticle-coupled oxytetracycline (OW); tungsten oxide nanoparticles (W), tungsten oxide nanoparticles coupled with ciprofloxacin and penicillin (CPW); tungsten oxide nanoparticles coupled with oxytetracycline and penicillin (OPW); tungsten oxide nanoparticles coupled with ampicillin and ciprofloxacin (ACW).

Comparison of the mean ZOI (mm) at different concentrations in each treatment group against bacteria (a = S. aureus, b = E. coli, c = mixed bacteria). WO3 in the figures means tungsten oxide nanoparticles.
3.4.1.1 Comparative ZOI (mm) among nanoparticle-coupled antibiotics
The current study revealed that S. aureus showed the highest ZOI in favor of CW, while the lowest was observed against W at concentrations of 1,000, and 10 µg/mL. At 1,000 µg/mL, CW significantly (p < 0.05) varied with the highest ZOI (31.00 ± 4.55 mm) compared to W; on the other hand, for CPW, a non-significant difference (p < 0.05) was observed compared to AW, OW, OPW, and ACW. The least ZOI (20.75 ± 2.06 mm) was found for W. The other groups exhibited non-significant differences (p > 0.05) from each other. There was a similar response at both 100 and 10 µg/mL among different groups: CW was significant (p < 0.05) compared with AW, W, CPW, OPW, and non-significant (p > 0.05) with OW and ACW. In the case of E. coli, OW was found to have the significantly highest ZOI (23.750 ± 0.957 mm), followed by CW and W (14.500 ± 0.577 mm) at 1,000 µg/mL. When exposed to 100 µg/mL, E. coli showed a significant difference (p < 0.05) for W with AW, OW, and CPW, while a non-significant difference (p > 0.05) was observed when compared with CW, OPW, and ACW. The order of ZOI among other treatment groups was as follows: OW > CPW > CW > ACW > OPW at 100 µg/mL tested against E. coli. The response of bacteria at 10 µg/mL indicated that CW had a significant difference with OW, W, and OPW, while AW, CPW, and ACW had a non-significant difference. The mixed culture bacteria showed the highest susceptibility in favor of CW at 1,000, 100, and 10 µg/mL, showing values of 31.33 ± 1.52, 19.00 ± 2.65, and 12.33 ± 0.58 mm, while the lowest was shown for W at 1,000 and 100 µg/mL with ZOI of 16.33 ± 0.58 and 11.67 ± 0.58 mm, respectively. However, AW showed the lowest ZOI (8.00 ± 1.00 mm) at 10 µg/mL when applied to a mixed bacterial culture. The order of ZOI of other preparations found at 1,000 µg/mL was as follows: CPW > ACW > OPW > OW > AW, while at 100 and 10 µg/mL, it was found to be CPW > OPW > ACW > OW > AW and ACW > OW > CPW > OPW > W, respectively, when these preparations were tested on mixed culture bacteria.
3.4.1.2 Comparative ZOI (mm) among different concentrations of treatments
The comparative response of S. aureus against different concentrations in the treatment groups showed significant differences (p < 0.05). The ZOI expressed by CW was found significantly different (p < 0.05) between 1,000 and 10 µg/mL, while a non-significant (p > 0.05) difference was observed at 100 µg/mL. All other treatment groups, AW, OW, W, CPW, ACW, OPW, and ACW, indicated significant differences (p < 0.05) at all concentrations (1,000, 100, and 10 µg/mL) (Figure 6a). The comparison of ZOI against E. coli in each treatment showed a significant difference (p < 0.05), except in OPW. The latter presented a non-significant (p > 0.05) difference between 1,000 and 100 µg/mL, while a significant difference (p < 0.05) between 1,000 and 10 µg/mL. However, a comparison between concentrations of 100 and 10 µg/mL was also found non-significant (p > 0.05) (Figure 6b). All the treatment groups at 1,000, 100, and 10 µg/mL concentrations showed significant differences (p < 0.05) between each other against a mixed combination of bacteria. The effectiveness of nanoparticle-coupled antibiotics increased in combined bacteria in the form of a mean ZOI (Figure 6c).
3.4.2 Measurement of MIC (µg/mL) of nanoparticle-coupled antibiotics
MIC, as the least concentration effective against bacteria, was noted at different time intervals. Two types of analyses were made: (a) comparison of MIC among nanoparticles at each concentration against each of the bacterial culture types (Tables 2–4) and (b) comparison of MIC at different time intervals (4, 8, 12, 16, 20, and 24 h). The treatment kept in contact with bacteria was made at each type of treatment for each of the bacterial culture types (Figure 7).
Comparison of MIC values (µg/mL) of different treatment groups at each time interval against S. aureus
| Treatment groups | Time interval | |||||
|---|---|---|---|---|---|---|
| 4 h | 8 h | 12 h | 16 h | 20 h | 24 h | |
| CW | 667 ± 258AB | 416.7 ± 129.1A | 187.5 ± 68.5B | 93.8 ± 34.2B | 41.67 ± 16.14B | 20.84 ± 8.07C |
| AW | 583.3 ± 204.1AB | 375.0 ± 136.9A | 333.3 ± 129.1A | 166.7 ± 64.5A | 72.9 ± 25.5AB | 52.08 ± 16.14A |
| OW | 750 ± 274AB | 416.7 ± 129.1A | 229.2 ± 51.0AB | 83.3 ± 32.3B | 46.88 ± 17.12AB | 26.04 ± 8.07BC |
| W | 833 ± 258A | 458.3 ± 102.1A | 229.2 ± 51.0AB | 104.2 ± 32.3AB | 83.3 ± 32.3A | 57.29 ± 12.76A |
| CPW | 375.0 ± 136.9B | 375.0 ± 136.9A | 187.5 ± 68.5B | 93.8 ± 34.2B | 52.13 ± 16.07AB | 28.65 ± 6.38BC |
| OPW | 667 ± 258AB | 416.7 ± 129.1A | 145.8 ± 51.0B | 104.2 ± 32.3AB | 57.29 ± 12.76AB | 46.88 ± 17.12AB |
| ACW | 375.0 ± 136.9B | 333.3 ± 129.1A | 166.7 ± 64.5B | 83.3 ± 32.3B | 46.88 ± 17.12AB | 23.44 ± 8.56C |
Different superscripts (capital letters) within columns indicate a significant difference among different treatments at each concentration against S. aureus. The same holds for E. coli and mixed culture (S. aureus + E. coli) tungsten oxide nanoparticle-coupled ciprofloxacin (CW); tungsten oxide nanoparticle-coupled ampicillin (AW); tungsten oxide nanoparticle-coupled oxytetracycline (OW); tungsten oxide nanoparticles (W), tungsten oxide nanoparticles coupled with ciprofloxacin and penicillin (CPW); tungsten oxide nanoparticles coupled with oxytetracycline and penicillin (OPW); tungsten oxide nanoparticles coupled with ampicillin and ciprofloxacin (ACW).
Comparison of MIC values (µg/mL) of different treatment groups at each time interval against E. coli
| Treatment groups | Time interval | |||||
|---|---|---|---|---|---|---|
| 4 h | 8 h | 12 h | 16 h | 20 h | 24 h | |
| CW | 667 ± 258AB | 375.0 ± 136.9AB | 291.7 ± 102.1AB | 145.8 ± 51.0ABC | 52.08 ± 16.14BC | 20.84 ± 8.07D |
| AW | 416.7 ± 129.1AB | 333.3 ± 129.1AB | 166.7 ± 64.5B | 114.6 ± 73.1ABC | 93.8 ± 34.2AB | 52.08 ± 16.14ABCD |
| OW | 667 ± 258AB | 416.7 ± 129.1AB | 187.5 ± 68.5AB | 104.2 ± 32.3BC | 57.29 ± 12.76ABC | 57.29 ± 12.76ABC |
| W | 750 ± 274A | 458.3 ± 102.1A | 333.3 ± 129.1A | 208.3 ± 64.5A | 104.2 ± 32.3A | 83.3 ± 32.3A |
| CPW | 333.3 ± 129.1B | 229.2 ± 51.0B | 166.7 ± 64.5B | 83.3 ± 32.3C | 41.67 ± 16.14C | 23.44 ± 8.56CD |
| OPW | 667 ± 258AB | 416.7 ± 129.1AB | 291.7 ± 102.1AB | 187.5 ± 68.5AB | 93.8 ± 34.2AB | 72.9 ± 25.5AB |
| ACW | 375.0 ± 136.9AB | 333.3 ± 129.1AB | 187.5 ± 68.5AB | 93.8 ± 34.2BC | 67.7 ± 30.7ABC | 41.67 ± 16.14BCD |
Different superscripts (capital letters) within columns indicate a significant difference among different treatments at each concentration against S. aureus. The same holds for E. coli and mixed culture (S. aureus + E. coli) tungsten oxide nanoparticle-coupled ciprofloxacin (CW); tungsten oxide nanoparticle-coupled ampicillin (AW); tungsten oxide nanoparticle-coupled oxytetracycline (OW); tungsten oxide nanoparticles (W), tungsten oxide nanoparticles coupled with ciprofloxacin and penicillin (CPW); tungsten oxide nanoparticles coupled with oxytetracycline and penicillin (OPW); tungsten oxide nanoparticles coupled with ampicillin and ciprofloxacin (ACW).
Comparison of MIC values (µg/mL) of different treatment groups at each time interval against mixed bacteria
| Treatment groups | Time interval | |||||
|---|---|---|---|---|---|---|
| 4 h | 8 h | 12 h | 16 h | 20 h | 24 h | |
| CW | 667 ± 289A | 500.0 ± 0.0A | 208.3 ± 72.2A | 166.7 ± 72.2A | 104.2 ± 36.1A | 83.3 ± 36.1A |
| AW | 667 ± 289A | 333.3 ± 144.3A | 208.3 ± 72.2A | 125.0 ± 0.0A | 62.50 ± 0.00A | 26.04 ± 9.02B |
| OW | 500.0 ± 0.0A | 333.3 ± 144.3A | 208.3 ± 72.2A | 166.7 ± 72.2A | 83.3 ± 36.1A | 52.1 ± 18.0AB |
| W | 333.3 ± 144.3A | 333.3 ± 144.3A | 208.3 ± 72.2A | 166.7 ± 72.2A | 62.50 ± 0.00A | 31.25 ± 0.00B |
| CPW | 667 ± 289A | 500.0 ± 0.0A | 333.3 ± 144.3A | 166.7 ± 72.2A | 83.3 ± 36.1A | 41.7 ± 18.0AB |
| OPW | 833 ± 289A | 500.0 ± 0.0A | 250.0 ± 0.0A | 166.7 ± 72.2A | 83.3 ± 36.1A | 41.7 ± 18.0AB |
| ACW | 833 ± 289A | 416.7 ± 144.3A | 333.3 ± 144.3A | 166.7 ± 72.2A | 104.2 ± 36.1A | 62.50 ± 0.0AB |
Different superscripts (capital letters) within columns indicate a significant difference among different treatments at each concentration against S. aureus. The same holds for E. coli and mixed culture (S. aureus + E. coli) tungsten oxide nanoparticle-coupled ciprofloxacin (CW); tungsten oxide nanoparticle-coupled ampicillin (AW); tungsten oxide nanoparticle-coupled oxytetracycline (OW); tungsten oxide nanoparticles (W), tungsten oxide nanoparticles coupled with ciprofloxacin and penicillin (CPW); tungsten oxide nanoparticles coupled with oxytetracycline and penicillin (OPW); tungsten oxide nanoparticles coupled with ampicillin and ciprofloxacin (ACW).

Comparison of MICs (µg/mL) among different incubation periods (intervals) at each treatment against (a) S. aureus, (b) E. coli, and (c) mixed bacterial (S. aureus + E. coli) culture. WO3 in the figure means tungsten oxide nanoparticles.
3.4.2.1 Comparison of MIC (µg/mL) among different treatments
There was a reciprocal response of MIC with that of the time interval of each treatment in this study. The study showed a significant difference (p < 0.05) of MIC among various treatments following 24 h of incubation when applied on S. aureus (Table 2). Comparison of MICs among different treatments at 4 h of incubation revealed that the lowest value of MIC was noted by both ACW and CPW (375.0 ± 136.9 µg/mL), while the highest was expressed by W, followed by OW, both OPW and CW, and AW. The trend for MIC comparison at 8 h of incubation revealed non-significant differences among most of the treatments. While at 12 h of incubation, there was an overlapping response of MICs with respect to statistical alphabets noted, and a similar response was noted at 16 h of incubation. At 24 h of incubation, CW showed the least concentration of MIC (20.84 ± 8.07 µg/mL), followed by ACW, OW, CPW, OPW, AW, and W.
The MIC values of E. coli bacteria against different treatment groups at various concentrations (Table 3) were different compared to those observed in the case of S. aureus. At 4 h incubation, W showed the significantly highest MIC (750 ± 274 µg/mL) compared to other treatment groups, while CPW had the lowest MIC (333.3 ± 129.1 µg/mL). There was a significant difference in MICs between W (458.3 ± 102.1 µg/mL) and CPW (229.2 ± 51.0 µg/mL), while all other groups showed a non-significant difference at 8 h. After 24 h of incubation, results indicated that CW, compared to other treatments, showed the lowest MIC (20.84 ± 8.07 µg/mL), while W (83.3 ± 32.3 µg/mL) showed the highest MIC.
The antibacterial activity of different treatments against mixed culture (Table 4) showed different trends than those of individual bacteria. All of the treatments at 4 h of incubation showed a non-significant difference (p > 0.05). The treatments CW, CPW, and OPW showed the highest MIC (500.0 ± 0.0 µg/mL), but a non-significant difference was observed among all treatments at 8 h. The 16 h of incubation indicated that AW had the lowest MIC (125.0 ± 0.0 µg/mL), while CW and ACW indicated higher values of MIC (104.2 ± 36.1 µg/mL), followed by OW, CPW, OPW, AW, and W at 20 h. A significant difference (p < 0.05) was seen at 24 h, and treatment AW had a lower MIC (26.04 ± 9.02 µg/mL) compared to others.
3.4.2.2 Comparison of MIC (µg/mL) among incubation periods
Comparison of MIC values were found to be significantly different between 4 and 8 h for each of CW, OPW, and W, while non-significant different MICs were observed among 12, 16, 20, and 24 h of incubation intervals when these treatments were applied on S. aureus (Figure 7a). Significant variations were observed were observed among different intervals of incubation when AW, OW, CPW, and ACW were applied to S. aureus. Generally, the last three intervals of incubation showed a non-significant difference in MICs in all of the preparations.
MIC’s comparison among different time intervals at each of the treatments against E. coli showed a variable response compared to those shown against S. aureus (Figure 7b). However, a non-significant difference was observed among the last three intervals of incubation (16, 20, and 24 h) at all treatments, while comparison with initial hours (4 and 8 h) remained significantly different (p < 0.05). Significant difference of MICs among 4 and 8 h and their comparison further with other incubation periods differed significantly when CW, OW, and CPW were applied on E. coli. Comparison of MIC among 8 and 12 h was non-significant with each other, while MIC at 12 h showed a non-significant difference at 16, 20, and 24 h at CW. At AW, MIC between the first two intervals was non-significant, and a similar response was observed among other incubation intervals. Trends in comparison of MIC responses observed at mixed bacterial culture were different from those observed in the case of individual bacterial culture among different intervals of incubation (Figure 7c). AW showed overlapping response of MICs among different hours of incubation; there was a non-significant difference in MIC observed at 4 h with those of 8, 12, and 16 h. Similarly, MICs at 20 and 24 h were non-significant when compared with those observed at 16, 20, and 24 h. There was no significant difference in MICs observed among all other conditions for 4 h of incubation for AW and ACW. Moreover, highly overlapping responses in terms of MICs were observed when comparing different hours of incubation at each of OW, W, CPW, and OPW.
3.5 Genotoxicity analysis
This dataset presents the DNA damage (measured in arbitrary units ± standard deviation) caused by tungsten trioxide (WO3) nanoparticles alone and in combination with various antibiotics, assessed at different concentrations (10, 1, 0.5, and 0.25 mg/mL) and time points (24 and 48 h). The DNA damage is compared with a negative control and a positive control (MMS). When compared to control groups, a statistically significant dose-dependent relationship (p ≤ 0.05) was observed in all treatment groups, suggesting that the nanoparticles and antibiotics had genotoxic effects. Table 5 displays the findings of DNA damage in A. cepa root meristems at various concentrations and time points. A direct dose–response association was evident by the enhanced DNA damage. All WO3 (alone) concentrations caused a considerable amount of DNA damage in comparison to the control group. The highest DNA damage was detected (57.00 ± 3.00) at 10 mg/mL when compared with the positive control MMS (66.15 ± 0.67), while the lowest value was 32.00 ± 2.00 for 0.25 mg/mL at 24 h, and a similar pattern was observed at 48 h. MMS indicated the highest damage compared to ciprofloxacin + WO3 (52.50 ± 8.50) against 10 mg/mL at 24 h and the least damage (32.50 ± 12.50) at 0.25 mg/mL, and had a significant difference at all concentrations after 48 h.
DNA damage (means ± SD) by comet assay of different treatment groups
| Treatments | Concentration (mg/mL) | DNA damage (Arbitrary Unit ± SD) | |
|---|---|---|---|
| 24 h | 48 h | ||
| Negative control | — | 10.22 ± 0.12E | 10.12 ± 0.11D |
| MMS | 10 | 66.15 ± 0.67A | 69.13 ± 0.60A |
| WO3 | 10 | 57.00 ± 3.00B | 59.00 ± 2.00B |
| 1 | 47.00 ± 1.00C | 48.00 ± 2.00C | |
| 0.5 | 38.50 ± 4.50D | 40.30 ± 4.50C | |
| 0.25 | 32.00 ± 2.00D | 40.00 ± 6.00C | |
| Negative control | — | 10.22 ± 0.12D | 10.12 ± 0.11D |
| MMS | 10 | 66.15 ± 0.67A | 69.13 ± 0.60A |
| Ciprofloxacin + WO3 | 10 | 52.50 ± 8.50AB | 64.50 ± 4.50A |
| 1 | 46.00 ± 1.00BC | 47.00 ± 10.00B | |
| 0.5 | 36.00 ± 1.00BC | 39.00 ± 3.00BC | |
| 0.25 | 32.50 ± 12.50C | 28.00 ± 10.00C | |
| Negative control | 10.22 ± 0.12D | 10.12 ± 0.11B | |
| MMS | 66.15 ± 0.67A | 69.13 ± 0.60A | |
| Ampicillin + WO3 | 10 | 66.30 ± 4.1A | 66.00 ± 8.00A |
| 1 | 58.00 ± 1.00B | 59.50 ± 3.50A | |
| 0.5 | 55.000 ± 1.00B | 56.5 ± 21.5A | |
| 0.25 | 45.00 ± 5.00C | 47.00 ± 15.00A | |
| Negative control | 10.22 ± 0.12D | 10.12 ± 0.11C | |
| MMS | 66.15 ± 0.67A | 69.13 ± 0.60A | |
| Oxytetracycline + WO3 | 10 | 49.50 ± 4.50B | 53.50 ± 12.50AB |
| 1 | 40.00 ± 0.00C | 42.00 ± 7.00B | |
| 0.5 | 40.500 ± 1.50BC | 41.50 ± 2.50B | |
| 0.25 | 39.50 ± 6.50C | 39.00 ± 4.00B | |
| Negative control | — | 10.22 ± 0.12E | 10.12 ± 0.11B |
| MMS | 10 | 66.15 ± 0.67A | 69.13 ± 0.60A |
| Oxytetracycline + penicillin + WO3 | 10 | 57.500 ± 1.500B | 58.00 ± 10.00A |
| 1 | 56.50 ± 0.500B | 55.50 ± 11.50A | |
| 0.5 | 49.00 ± 0.00C | 50.00 ± 6.00A | |
| 0.25 | 42.00 ± 4.00D | 48.50 ± 9.50A | |
| Negative control | — | 10.22 ± 0.12C | 10.12 ± 0.11C |
| MMS | 10 | 66.15 ± 0.67A | 69.13 ± 0.60A |
| Ampicillin + Ciprofloxacin + WO3 | 10 | 58.50 ± 4.50A | 59.500 ± 1.50AB |
| 1 | 47.500 ± 0.50B | 47.50 ± 12.50B | |
| 0.5 | 41.00 ± 6.00B | 46.00 ± 11.00B | |
| 0.25 | 40.50 ± 3.50B | 45.50 ± 3.50B | |
| Negative control | 10.22 ± 0.12C | 10.12 ± 0.11C | |
| MMS | 66.15 ± 0.67A | 69.13 ± 0.60A | |
| Ciprofloxacin + penicillin + WO3 | 10 | 63.00 ± 6.00AB | 64.0 ± 11.0AB |
| 1 | 54.00 ± 4.00B | 55.00 ± 1.00B | |
| 0.5 | 54.50 ± 6.50B | 54.00 ± 1.00B | |
| 0.25 | 52.50 ± 3.50B | 51.50 ± 1.500B | |
MMS = methyl methane sulfonate, SD = standard deviation, negative control included distilled water. Different letters in the same columns for each treatment and time are statistically significant (p ≤ 0.05). WO3 in the table means tungsten oxide nanoparticles.
DNA damage against ampicillin + WO3 showed that MMS had a non-significant difference at 10 mg/mL in terms of concentrations and time interval, while the least damage was observed after 24 and 48 h with respect to MMS. Less DNA damage was observed by the negative control (10.22 ± 0.12), followed by the 0.25 mg/mL (39.50 ± 6.50) dose of oxytetracycline + WO3. In contrast, the highest was observed by MMS (66.15 ± 0.67), followed by the 10 µg/mL (49.50 ± 4.50) concentration at 24 h. DNA damage indicated that the treatment group oxytetracycline + penicillin + WO3 had the highest damage by positive control MMS, followed by 10 mg/mL > 1 mg/mL > 0.5 mg/mL > 0.25 mg/mL in terms of time interval (24 and 48 h). Ampicillin + ciprofloxacin + WO3 and ciprofloxacin + penicillin + WO3 presented a dose–response relation with respect to time interval, and indicated a significant difference when compared with positive and negative controls.
The extent of DNA damage in onion cells by NP-coupled antibiotics is shown in Figure 8. This figure reinforces that both the type and number of antibiotics combined with WO3 influence the severity of DNA damage, supporting the dose- and combination-dependent findings. The damage to DNA indicated by comets, and each comet (tail DNA) is assigned a score from 0 to 4 or 0 to 5, depending on the extent of DNA migration, with higher scores reflecting more damage.

Degree of DNA damage in onion cells by nanoparticle-coupled antibiotics: (a) ciprofloxacin + WO3 nanoparticles, (b) ampicillin + WO3 nanoparticles, (c) oxytetracycline + WO3 nanoparticles, (d) WO3 nanoparticles, (e) ciprofloxacin + penicillin + WO3 nanoparticles, (f) oxytetracycline + penicillin + WO3 nanoparticles, and (g) ampicillin + ciprofloxacin + WO3 nanoparticles. Numbers indicate damage to DNA, where 0 represents no damage, 1 represents mild damage, 2 represents moderate damage, 3 represents severe damage, and 4 represents complete damage to DNA.
4 Discussion
4.1 Nanoparticles characterization
The properties of nanomaterials based on the transition metal tungsten (W), including their size distribution, specific surface area, overall particle composition, and metal oxide–support interaction, are crucial in the advancement of several technological applications. The characterization of WO3 nanoparticles in this study was similar to that in Liu et al. [26], who reported that the synthetic product was found to be WO3 nanoparticles based on the XRD pattern plotted between the 2θ (°) value and associated indices. The tungsten oxide (WO2.95) exhibited a peak at 23.31°. W-metallic phases were represented by the peaks at 55.52° and 60.96°, respectively [19]. The SEM findings of WO3 nanoparticles revealed that they were oval-shaped, with rounded ends at different points. Additionally, it was noted that the nanoparticles were not completely spherical. Every peak showed that the product had a high degree of crystallinity [9]. According to Habibi et al. [27], most nanoparticles are agglomerated, but some are well separated. Over flake-like aggregates, the materials grouped into tiny and fractured clusters, were comparable to the present study. When the tungsten weight percentage was increased during the synthesis, there were no apparent alterations in the morphology [28]. According to Bashir et al. [9], the average size of the particle was 22.5 nm, which was contradictory to the current investigation. Sone et al. [29] found that the average sizes of the nanoparticles were in the range of 20–100 nm. The average size of the nanoparticles was roughly 62.5 nm. The SEM image indicated that the morphology and size of the powders (tungsten carbide) changed and increased due to the agglomeration or particle coalescence after the heat treatment [30].
Prominent bands found in the FTIR analysis of pure WO3 nanoparticles showed that the hydrothermal synthesis was successful. The O–H stretching [31] may have resulted from water adsorption, as shown by key bands at 3,481 cm−1, whereas CTAB surfactants may be responsible for the band at 3,080 cm−1, which is similar to the current study. The O–H bending in hydrothermally prepared WO3 is indicated by the 1,649 cm−1 band. The stretching vibration of bridging oxygen atoms (W–O–W) is shown by the 799 cm−1 band, whereas the 1,435 cm−1 band was linked to CTAB [32], which is similar to the present investigation. Bands at 3,086, 1,755, 1,585, and 799 cm−1 were observed for WO3-ampicillin-coated samples [33], indicating interactions between WO3 and ampicillin. The literature is in agreement with the current study, which showed that the W–O stretching deformation band was observed at 815 cm−1. The other band was at 970 cm−1, which was the stretching vibration mode of W═O bonds. These types of W═O bonds were attributed to the monoclinic WO3 crystal structure [30].
4.2 Antibacterial activity
The current study was found in agreement with the findings of Shkir et al. [34], who found 5% Y-doped WO3 NRs (yttrium-doped tungsten oxide nanorods) exhibiting significant ZOI against S. aureus and E. coli at a concentration of 100 μg/mL. However, in agreement with the current study, Subramani and Nagarajan [35] reported higher sensitivity of S. aureus against Eu:WO3 nanoparticles. Selvaraj and his colleagues [36] reported a 27 mm ZOI in E. coli in the case of citrate-capped gold NPs, which is in contradiction to the findings of the current study. Similarly, contrary to the findings of the current study, Singh et al. [37] reported a 21 mm ZOI when 1,000 mg of CuO nanoparticles were applied on E. coli. This discrepancy might be due to the unique mechanism of action of ROS, which are produced by copper ions inside the bacterial cells. There are changes in cellular signaling and disruption of nucleic acid, yielding helical form [38]. Our findings were consistent with those of Banoee et al. [39], who demonstrated that the combination of ciprofloxacin and ampicillin nanoparticles enhanced activity against pathogens.
The findings of MIC in the current study were in line with previous studies on tungsten oxide nanoparticle-coupled with oxytetracycline (26–65 µg/mL) and ampicillin (52 µg/mL) against single and mixed bacterial cultures of S. aureus and E. coli [40]. Similar findings were also reported by Bashir et al. [9], who used tungsten oxide coupled ampicillin (39–156 µg/mL), tungsten oxide nanoparticle-coupled penicillin (26–104 µg/mL), and tungsten oxide nanoparticle-coupled ciprofloxacin (13–78 µg/mL) against single and mixed bacterial cultures of S. aureus and E. coli. Contrary to the findings of the current study, Syed et al. [41] reported 1,500 µg/mL of MIC against bacterial strains. On the other hand, Duan et al. [42] found that WO3−x nanodots showed increased antimicrobial activity in the presence of sunlight; a 30-min exposure to sunlight at 50 μg/mL, WO3−x nanodots resulted in a 70% reduction in E. coli viability when compared to no exposure. The current study findings are in contrast to another study, which showed that the WO3 nanoparticles had potent antibacterial action at 125 and 250 mg/mL [43]. They effectively produced tungsten trioxide nanoparticles with a monoclinic structure. A variety of bacteria, including Gram-positive and Gram-negative isolates of Salmonella typhimurium, E. coli, Listeria monocytogenes, and Staphylococcus aureus, were used to evaluate the antibacterial properties of WO3 nanoparticles. Contrary to the findings of current study, Bankier et al. [44] found no antibacterial response of single elemental NP (SENPs) WC against S. aureus (>99% ± 0.14 live), while nanoparticle combinations showed significant anti-bacterial activity (P < 0.01). According to this study, the pharmaceutical and healthcare industries can increase the antibacterial efficacy of treating morphologically diverse pathogens by combining specific metallic nanoparticles.
The difference in findings of the current study from others may be attributed to various factors. For example, the study demonstrated that both S. aureus and E. coli were inhibited when the concentration of tungsten disulfide (WS2) nanosheets was increased and by extending the incubation period. WS2 nanosheets stick to the surfaces of bacteria, which effectively inhibit their ability to proliferate. This can be explored by the fact that WS2 nanosheets come into close contact with a bacterial cell membrane, and the integrity of the membrane may be seriously compromised, which can lead to cell death [45]. The thin film coating of tungsten oxide showed significant antibacterial potential against E. coli after 24 h, which might be due to the small particle size [46]. Membrane stress and the photocatalytic capabilities of WO3−X nanodots are responsible for their antibacterial potential, while production of ROS and the damage to bacterial membranes are the main causes of its antibacterial action [42]. Furthermore, additional experimental results have shown that the degree of degradation, particle size, agglomeration process, and exposure duration to microbial cells all influence the antibacterial efficacy of nanoscale metal oxides. Moreover, it was reported that NPs may also work by making direct contact with the bacterial cell wall without having to enter the cell, and they are not affected by the majority of antibiotic resistance mechanisms. This suggests that NPs may be less likely to promote bacterial resistance than antibiotics. As a result, interest in novel NP-based materials with antibacterial properties has increased [47].
4.3 Toxicity of nanoparticle-coupled antibiotics
According to reports, tungsten nanoparticles, or W-NPs, are less harmful than silver and numerous other substances [48]. Currently, the Comet assay (CA) and the micronucleus (MN) tests are regarded as essential genotoxic tests for determining the genotoxicity of substances. The current study was comparable to that of Ciğerci et al. [49], who demonstrated the dose-dependent relationship of CoCl2 on earthworm DNA damage, demonstrating that higher concentrations of CoCl2 result in greater DNA damage. According to the literature, SiO2NPs can cause oxidative stress and the dose-dependent production of 8-OH-dG [50], which ultimately leads to DNA damage brought on by oxidative stress [51]. By using the alkaline comet assay, amorphous silica nanoparticles (20–240 nm) did not exhibit any genotoxic effects on 3T3-L1 fibroblasts or A549 human lung epithelial carcinoma cells [52]. Thus, further research is still required to assess the genotoxic effects and processes of silica nanoparticles in various organisms and test systems.
Similar research was conducted on the DNA damage caused by 2-CP (2-chlorophenol) on A. cepa root meristematic cells, which was evaluated using the Comet assay between 24 and 96 h. When compared to the negative control, cells treated with 2-CP showed significant dose-dependent DNA damage over 24, 48, 72, and 96 h. 2-CP (50 mg/L) for 72 h caused the greatest amount of DNA damage (165 ± 2), while 12.5 mg/L 2-CP for 24 h caused the least amount of DNA damage (43 ± 2). No matter the period, DNA damage at 50 mg/L was consistent and comparable to MMS [53]. Carassius auratus (Goldfish) produced more ROS and superoxide dismutase and catalase in response to exposure to 2-CP, which caused oxidative stress [54]. In human gingival fibroblasts, 2-CP also caused double-strand breaks in DNA [55]. Similar to the current study, Panda et al. [56] examined how cultivated Allium cepa cells treated with silver ions (Ag+), silver complexes (AgCl), and capped (AgNP-P) and uncapped (AgNP-S) silver nanoparticles induced cellular death. Capped silver nanoparticles were the least poisonous form of silver, according to scientists, who also observed the induced cell death. Furthermore, it should be noted that one crucial factor in determining particle toxicity, is the nanoparticle size. However, further research has to be done on this subject. Determining the trend of silver nanoparticle toxicity (genotoxicity) can be challenging because of the several ways that nanoparticles are manufactured, their different sizes, the presence or absence of capping agents, and finally, the different kinds of toxicity evaluation assays. Two noteworthy advancements that could be highlighted are the fact that silver nanoparticles are less toxic than silver ions [57] and that toxicity is decreased by nanoparticle encapsulation [56]. Similarly, the tungsten oxide nanoparticles found to be less toxic and when coupled with antibiotics can be used as efficient antibacterial agents.
5 Conclusion
The study revealed the ability of tungsten oxide nanoparticles to be effectively coupled with oxytetracycline, ampicillin, ciprofloxacin, and penicillin with distinct boundaries and successful size distribution. These treatment groups showed significant ZOIs when applied to single and mixed cultures of S. aureus and E. coli. Similarly, the lowest concentration of these treatments exhibited the highest antibacterial activity. Overall, ciprofloxacin coupled with tungsten oxide nanoparticles proved to be the most effective antibacterial candidates against single and mixed cultures, followed by the highest responses exhibited by WO3 nanoparticles coupled ampicillin and WO3 nanoparticles coupled with double antibiotics (ampicillin plus ciprofloxacin). Biosafety profiles revealed dose- and time-dependent DNA damage of the products, while the coupled treatments showed a significant reduction in genotoxicity compared to the positive control, indicating these to be safer to apply on the host. Further trials on lab and experimental animals are required for product formulation alongside safety profiles. Research on tungsten-based nanoparticles offers an effective means to fight against bacterial infections and to mitigate the worldwide problem of antibiotic resistance.
Acknowledgments
The authors extend their appreciation to the “Ongoing Research Funding Program” (ORF-2025-693), King Saud University, Riyadh, Saudi Arabia. The authors also acknowledge Major Rahat Afzal and Brig. (R) Mukhtar Ahmad and Dr Talha Riaz, Houbara Foundation International, Pakistan, for their support during sample collection.
-
Funding information: The “Ongoing Research Funding Program” (ORF-2025-693), King Saud University, Riyadh, Saudi Arabia.
-
Author contributions: Maham Fatima conducted research, gathered data, formal analysis, and prepared an initial draft; Amjad Islam Aqib conceived the idea, analyzed data, and revised the manuscript; Tasleem Kausar analyzed data and revised the manuscript; Arslan Bashir collected data; and Muhammad Shoaib and Farid Shokry Ataya revised the manuscript. All authors have accepted responsibility for the entire content of this manuscript and approved its submission.
-
Conflict of interest: The authors state no conflict of interest.
-
Data availability statement: The datasets generated and/or analyzed during the current study are available from the corresponding author on reasonable request.
References
[1] Guillaume O, Butnarasu C, Visentin S, Reimhult E. Interplay between biofilm microenvironment and pathogenicity of Pseudomonas aeruginosa in cystic fibrosis lung chronic infection. Biofilm. 2022;4:100089.10.1016/j.bioflm.2022.100089Search in Google Scholar PubMed PubMed Central
[2] Hannan A, Du X, Maqbool B, Khan A. Nanoparticles as potent allies in combating antibiotic resistance: a promising frontier in antimicrobial therapy. Pak Vet J. 2024;44(4):957–67.Search in Google Scholar
[3] Sharifi M, Attar F, Saboury AA, Akhtari K, Hooshmand N, Hasan A, et al. Plasmonic gold nanoparticles: Optical manipulation, imaging, drug delivery and therapy. J Control Release. 2019;311:170–89.10.1016/j.jconrel.2019.08.032Search in Google Scholar PubMed
[4] Shah DD, Chorawala MR, Mansuri MK, Parekh PS, Singh S, Prajapati BG. Biogenic metallic nanoparticles: from green synthesis to clinical translation. Naunyn-Schmiedeberg’s Arch Pharmacol. 2024;397(11):8603–31.10.1007/s00210-024-03236-ySearch in Google Scholar PubMed
[5] Kapoor DU, Patel RJ, Gaur M, Parikh S, Prajapati BG. Metallic and metal oxide nanoparticles in treating Pseudomonas aeruginosa infections. J Drug Deliv Sci Technol. 2024;91:105290.10.1016/j.jddst.2023.105290Search in Google Scholar
[6] Zhang H, Li Z, Dai C, Wang P, Fan S, Yu B, et al. Anti-bacterial properties and mechanism of selenium nanoparticles synthesized by Providencia sp. DCX. Environ Res. 2021;194:110630.10.1016/j.envres.2020.110630Search in Google Scholar PubMed
[7] Kumar A, Shah SR, Jayeoye TJ, Kumar A, Parihar A, Prajapati B, et al. Biogenic metallic nanoparticles: Biomedical, analytical, food preservation, and applications in other consumable products. Front Nanotechnol. 2023;5:1175149.10.3389/fnano.2023.1175149Search in Google Scholar
[8] Modi S, Inwati GK, Gacem A, Saquib Abullais S, Prajapati R, Yadav VK, et al. Nanostructured antibiotics and their emerging medicinal applications: an overview of nanoantibiotics. Antibiotics. 2022;11(6):708.10.3390/antibiotics11060708Search in Google Scholar PubMed PubMed Central
[9] Bashir A, Khan SR, Aqib AI, Shafique L, Ataya FS. Multifunctional integration of tungsten oxide (WO3) coating: A versatile approach for enhanced performance of antibiotics against single mixed bacterial infections. Microb Pathog. 2024;189:106571.10.1016/j.micpath.2024.106571Search in Google Scholar PubMed
[10] Thambirajoo M, Maarof M, Lokanathan Y, Katas H, Ghazalli NF, Tabata Y, et al. Potential of nanoparticles integrated with anti-bacterial properties in preventing biofilm and antibiotic resistance. Antibiotics. 2021;10(11):1338.10.3390/antibiotics10111338Search in Google Scholar PubMed PubMed Central
[11] Zielińska A, Costa B, Ferreira MV, Miguéis D, Louros JM, Durazzo A, et al. Nanotoxicology and nanosafety: Safety-by-design and testing at a glance. Int J Environ Res Public Health. 2020;17(13):4657.10.3390/ijerph17134657Search in Google Scholar PubMed PubMed Central
[12] Arnold KE, Williams NJ, Bennett M. ‘Disperse abroad in the land’: the role of wildlife in the dissemination of antimicrobial resistance. Biol Lett. 2016;12(8):20160137.10.1098/rsbl.2016.0137Search in Google Scholar PubMed PubMed Central
[13] Abril‐Colón I, Alonso JC, Palacín C, Álvarez‐Martínez JM, Ucero A. Short‐distance nocturnal migration in an island endemic bustard. Ibis. 2022;164(4):1145–59.10.1111/ibi.13061Search in Google Scholar
[14] Rahman MT, Sobur MA, Islam MS, Ievy S, Hossain MJ, El Zowalaty ME, et al. Zoonotic diseases: etiology, impact, and control. Microorganisms. 2020;8(9):1405.10.3390/microorganisms8091405Search in Google Scholar PubMed PubMed Central
[15] Attarilar S, Yang J, Ebrahimi M, Wang Q, Liu J, Tang Y, et al. The toxicity phenomenon and the related occurrence in metal and metal oxide nanoparticles: a brief review from the biomedical perspective. Front Bioeng Biotechnol. 2020;8:822.10.3389/fbioe.2020.00822Search in Google Scholar PubMed PubMed Central
[16] Ahmed A, Ijaz M, Khan JA, Anjum AA. Molecular characterization and therapeutic insights into biofilm positive Staphylococcus aureus isolated from bovine subclinical mastitis. Pak Vet J. 2022;42(4):584–90.10.29261/pakvetj/2022.078Search in Google Scholar
[17] Wise Sr JP, Goodale BC, Wise SS, Craig GA, Pongan AF, Walter RB, et al. Silver nanospheres are cytotoxic and genotoxic to fish cells. Aquat Toxicol. 2010;97(1):34–41.10.1016/j.aquatox.2009.11.016Search in Google Scholar PubMed PubMed Central
[18] Beyth N, Houri-Haddad Y, Domb A, Khan W, Hazan R. Alternative antimicrobial approach: nano‐antimicrobial materials. Evid‐Based Complement Altern Med. 2015;2015(1):246012.10.1155/2015/246012Search in Google Scholar PubMed PubMed Central
[19] Kumar VB, Mohanta D. Formation of nanoscale tungsten oxide structures and colouration characteristics. Bull Mater Sci. 2011;34(3):435–42.10.1007/s12034-011-0117-1Search in Google Scholar
[20] Anwar MA, Aqib AI, Ashfaq K, Deeba F, Khan MK, Khan SR, et al. Antimicrobial resistance modulation of MDR E. coli by antibiotic coated ZnO nanoparticles. Microb Pathogen. 2020;148:104450.10.1016/j.micpath.2020.104450Search in Google Scholar PubMed
[21] Murtaza M, Aqib AI, Khan SR, Muneer A, Ali MM, Waseem A, et al. Sodium alginate-based MgO nanoparticles coupled antibiotics as safe and effective antimicrobial candidates against Staphylococcus aureus of Houbara Bustard Birds. Biomedicines. 2023;11(7):1959.10.3390/biomedicines11071959Search in Google Scholar PubMed PubMed Central
[22] Bergey DH. Bergey’s manual of determinative bacteriology. 9th edn. Baltimore, Maryland: Williams & Wilkins; 1994.Search in Google Scholar
[23] Ali MM, Fatima A, Nawaz S, Rehman A, Javed M, Nadeem A. Cytotoxic and genotoxic evaluation of bisphenol S on onion root tips by Allium cepa and comet tests. Environ Sci Pollut Res. 2022;29(59):88803–11.10.1007/s11356-022-21888-2Search in Google Scholar PubMed
[24] Karaismailoğlu C. Cytotoxic and genotoxic effects of oxyfluorfen on the somatic cells of Allium cepa. Kahramanmaraş Sütçü İmam Üniv Tarım Doğa Derg. 2022;25(2):207–14.10.18016/ksutarimdoga.vi.864929Search in Google Scholar
[25] Ozel CA, Unal F, Avuloglu-Yilmaz E, Erikel E, Mirici S, Yuzbasioglu D. Determination of genotoxic damages of picloram and dicamba with comet assay in Allium cepa rooted in tissue culture and distilled water. Mol Biol Rep. 2022;49(12):11273–80.10.1007/s11033-022-07712-7Search in Google Scholar PubMed
[26] Liu H, Peng T, Ke D, Peng Z, Yan C. Preparation and photocatalytic activity of dysprosium doped tungsten trioxide nanoparticles. Mater Chem Phys. 2007;104(2–3):377–83.10.1016/j.matchemphys.2007.03.028Search in Google Scholar
[27] Habibi MH, Kamrani R, Mokhtari R. Fabrication and characterization of copper nanoparticles using thermal reduction: The effect of nonionic surfactants on size and yield of nanoparticles. Microchim Acta. 2010;171(1):91–5.10.1007/s00604-010-0413-2Search in Google Scholar
[28] Aguilera F, Cota-Leal M, Luque P, Olivas A. Tungsten oxide nanomaterial interactions below monolayer coverage. J Ovonic Res. 2024;20(3):405–15.10.15251/JOR.2024.203.405Search in Google Scholar
[29] Sone BT, Sithole J, Bucher R, Mlondo SN, Ramontja J, Ray SS, et al. Synthesis and structural characterization of tungsten trioxide nanoplatelet-containing thin films prepared by Aqueous Chemical Growth. Thin Solid Films. 2012;522:164–70.10.1016/j.tsf.2012.08.032Search in Google Scholar
[30] Kaya N, Yavaş A, Sütçü M, Karaman M. Photocatalytic performance and characterization of tungsten oxide powders recycled from cutting tool wastes. Int J Appl Ceram Technol. 2025;22(6):e70017.10.1111/ijac.70017Search in Google Scholar
[31] Díaz-Reyes J, Dorantes-García V, Pérez-Benítez A, Balderas-López JA. Obtaining of films of tungsten trioxide (WO3) by resistive heating of a tungsten filament. Superficies Vacío. 2008;21(2):12–7.Search in Google Scholar
[32] Wang G, Mu Q, Chen T, Wang Y. Synthesis, characterization and photoluminescence of CeO2 nanoparticles by a facile method at room temperature. J Alloy Compd. 2010;493(1–2):202–7.10.1016/j.jallcom.2009.12.053Search in Google Scholar
[33] Yayapao O, Thongtem T, Phuruangrat A, Thongtem S. CTAB-assisted hydrothermal synthesis of tungsten oxide microflowers. J Alloy Compd. 2011;509(5):2294–9.10.1016/j.jallcom.2010.10.204Search in Google Scholar
[34] Shkir M, Ashraf IM, Ahmed FB, Hasan N. Enhanced photocatalytic and anti-bacterial properties of Yttrium-doped tungsten oxide (WO₃) nanorods synthesized via hydrothermal method for environmental remediation. J Alloy Compd. 2025;1010:177857.10.1016/j.jallcom.2024.177857Search in Google Scholar
[35] Subramani T, Nagarajan SK. Structural, optical and morphological properties of Eu rare earth doped WO3 nanoparticles enhanced photocatalytic for waste water treatment and anti-bacterial activities. Ceram Int. 2024;50(22):44822–32.10.1016/j.ceramint.2024.08.317Search in Google Scholar
[36] Selvaraj V, Alagar M. Analytical detection and biological assay of antileukemic drug 5-fluorouracil using gold nanoparticles as probe. Int J Pharm. 2007;337(1–2):275–81.10.1016/j.ijpharm.2006.12.027Search in Google Scholar PubMed
[37] Singh P, Singh KR, Singh J, Das SN, Singh RP. Tunable electrochemistry and efficient anti-bacterial activity of plant-mediated copper oxide nanoparticles synthesized by Annona squamosa seed extract for agricultural utility. RSC Adv. 2021;11(29):18050–60.10.1039/D1RA02382ASearch in Google Scholar PubMed PubMed Central
[38] Gunawan C, Teoh WY, Marquis CP, Amal R. Cytotoxic origin of copper (II) oxide nanoparticles: comparative studies with micron-sized particles, leachate, and metal salts. ACS Nano. 2011;5(9):7214–25.10.1021/nn2020248Search in Google Scholar PubMed
[39] Banoee M, Seif S, Nazari ZE, Jafari‐Fesharaki P, Shahverdi HR, Moballegh A, et al. ZnO nanoparticles enhanced anti-bacterial activity of ciprofloxacin against Staphylococcus aureus and Escherichia coli. J Biomed Mater Res Part B: Appl Biomater. 2010;93(2):557–61.10.1002/jbm.b.31615Search in Google Scholar PubMed
[40] Zia S, Peng S, Bashir A, Kausar T, Khan SR, Muneer A, et al. Resistance modulation of individual and polymicrobial culture of S. aureus and E. coli through nanoparticle-coupled antibiotics. Biomedicines. 2023;11(11):2988.10.3390/biomedicines11112988Search in Google Scholar PubMed PubMed Central
[41] Syed MA, Manzoor U, Shah I, Bukhari SH. Anti-bacterial effects of Tungsten nanoparticles on the Escherichia coli strains isolated from catheterized urinary tract infection (UTI) cases and Staphylococcus aureus. New Microbiol. 2010;33(4):329–35.Search in Google Scholar
[42] Duan G, Chen L, Jing Z, De Luna P, Wen L, Zhang L, et al. Robust anti-bacterial activity of tungsten oxide (WO3-x) nanodots. Chem Res Toxicol. 2019;32(7):1357–66.10.1021/acs.chemrestox.8b00399Search in Google Scholar PubMed
[43] Habtemariam AB, Alemu Y. Synthesis of WO3 nanoparticles using Rhamnus prinoides leaf extract and evaluation of its anti-bacterial activities. Biointerface Res Appl Chem. 2021;12(1):529–36.10.33263/BRIAC121.529536Search in Google Scholar
[44] Bankier C, Matharu RK, Cheong YK, Ren GG, Cloutman-Green E, Ciric L. Synergistic anti-bacterial effects of metallic nanoparticle combinations. Sci Rep. 2019;9(1):16074.10.1038/s41598-019-52473-2Search in Google Scholar PubMed PubMed Central
[45] Liu X, Duan G, Li W, Zhou Z, Zhou R. Membrane destruction-mediated anti-bacterial activity of tungsten disulfide (WS2). RSC Adv. 2017;7(60):37873–80.10.1039/C7RA06442JSearch in Google Scholar
[46] Tan GL, Tang D, Dastan D, Jafari A, Shi Z, Chu QQ, et al. Structures, morphological control, and anti-bacterial performance of tungsten oxide thin films. Ceram Int. 2021;47(12):17153–60.10.1016/j.ceramint.2021.03.025Search in Google Scholar
[47] Mansoor A, Mehmood M, Ul Hassan SM, Ali MI, Badshah M, Jamal A. Anti-bacterial effect of titanium-oxide nanoparticles and their application as alternative to antibiotics. Pak Vet J. 2023;43(2):269–75.10.29261/pakvetj/2023.039Search in Google Scholar
[48] Lok CN, Ho CM, Chen R, He QY, Yu WY, Sun H, et al. Silver nanoparticles: partial oxidation and anti-bacterial activities. JBIC J Biol Inorg Chem. 2007;12(4):527–34.10.1007/s00775-007-0208-zSearch in Google Scholar PubMed
[49] Ciğerci İH, Ali MM, Kaygısız ŞY, Liman R. Genotoxicity assessment of cobalt chloride in Eisenia hortensis earthworms coelomocytes by comet assay and micronucleus test. Chemosphere. 2016;144:754–7.10.1016/j.chemosphere.2015.09.053Search in Google Scholar PubMed
[50] Liman R, Acikbas Y, Ciğerci İH, Ali MM, Kars MD. Cytotoxic and genotoxic assessment of silicon dioxide nanoparticles by allium and comet tests. Bull Environ Contam Toxicol. 2020;104(2):215–21.10.1007/s00128-020-02783-3Search in Google Scholar PubMed
[51] Gong C, Tao G, Yang L, Liu J, He H, Zhuang Z. The role of reactive oxygen species in silicon dioxide nanoparticle-induced cytotoxicity and DNA damage in HaCaT cells. Mol Biol Rep. 2012;39(4):4915–25.10.1007/s11033-011-1287-zSearch in Google Scholar PubMed
[52] Park MV, Annema W, Salvati A, Lesniak A, Elsaesser A, Barnes C, et al. In vitro developmental toxicity test detects inhibition of stem cell differentiation by silica nanoparticles. Toxicol Appl Pharmacol. 2009;240(1):108–16.10.1016/j.taap.2009.07.019Search in Google Scholar PubMed
[53] Küçük D, Liman R. Cytogenetic and genotoxic effects of 2-chlorophenol on Allium cepa L. root meristem cells. Environ Sci Pollut Res. 2018;25(36):36117–23.10.1007/s11356-018-3502-0Search in Google Scholar PubMed
[54] Luo Y, Sui YX, Wang XR, Tian Y. 2-chlorophenol induced hydroxyl radical production in mitochondria in Carassius auratus and oxidative stress–An electron paramagnetic resonance study. Chemosphere. 2008;71(7):1260–8.10.1016/j.chemosphere.2007.11.066Search in Google Scholar PubMed
[55] Shehata M, Durner J, Thiessen D, Shirin M, Lottner S, Van Landuyt K, et al. Induction of DNA double-strand breaks by monochlorophenol isomers and ChKM in human gingival fibroblasts. Arch Toxicol. 2012;86(9):1423–9.10.1007/s00204-012-0861-zSearch in Google Scholar PubMed
[56] Panda KK, Achary VM, Krishnaveni R, Padhi BK, Sarangi SN, Sahu SN, et al. In vitro biosynthesis and genotoxicity bioassay of silver nanoparticles using plants. Toxicol Vitro. 2011;25(5):1097–105.10.1016/j.tiv.2011.03.008Search in Google Scholar PubMed
[57] Gaiser BK, Fernandes TF, Jepson MA, Lead JR, Tyler CR, Baalousha M, et al. Interspecies comparisons on the uptake and toxicity of silver and cerium dioxide nanoparticles. Environ Toxicol Chem. 2012;31(1):144–54.10.1002/etc.703Search in Google Scholar PubMed
© 2025 the author(s), published by De Gruyter
This work is licensed under the Creative Commons Attribution 4.0 International License.
Articles in the same Issue
- Research Articles
- MHD radiative mixed convective flow of a sodium alginate-based hybrid nanofluid over a convectively heated extending sheet with Joule heating
- Experimental study of mortar incorporating nano-magnetite on engineering performance and radiation shielding
- Multicriteria-based optimization and multi-variable non-linear regression analysis of concrete containing blends of nano date palm ash and eggshell powder as cementitious materials
- A promising Ag2S/poly-2-amino-1-mercaptobenzene open-top spherical core–shell nanocomposite for optoelectronic devices: A one-pot technique
- Biogenic synthesized selenium nanoparticles combined chitosan nanoparticles controlled lung cancer growth via ROS generation and mitochondrial damage pathway
- Fabrication of PDMS nano-mold by deposition casting method
- Stimulus-responsive gradient hydrogel micro-actuators fabricated by two-photon polymerization-based 4D printing
- Physical aspects of radiative Carreau nanofluid flow with motile microorganisms movement under yield stress via oblique penetrable wedge
- Effect of polar functional groups on the hydrophobicity of carbon nanotubes-bacterial cellulose nanocomposite
- Review in green synthesis mechanisms, application, and future prospects for Garcinia mangostana L. (mangosteen)-derived nanoparticles
- Entropy generation and heat transfer in nonlinear Buoyancy–driven Darcy–Forchheimer hybrid nanofluids with activation energy
- Green synthesis of silver nanoparticles using Ginkgo biloba seed extract: Evaluation of antioxidant, anticancer, antifungal, and antibacterial activities
- A numerical analysis of heat and mass transfer in water-based hybrid nanofluid flow containing copper and alumina nanoparticles over an extending sheet
- Investigating the behaviour of electro-magneto-hydrodynamic Carreau nanofluid flow with slip effects over a stretching cylinder
- Electrospun thermoplastic polyurethane/nano-Ag-coated clear aligners for the inhibition of Streptococcus mutans and oral biofilm
- Investigation of the optoelectronic properties of a novel polypyrrole-multi-well carbon nanotubes/titanium oxide/aluminum oxide/p-silicon heterojunction
- Novel photothermal magnetic Janus membranes suitable for solar water desalination
- Green synthesis of silver nanoparticles using Ageratum conyzoides for activated carbon compositing to prepare antimicrobial cotton fabric
- Activation energy and Coriolis force impact on three-dimensional dusty nanofluid flow containing gyrotactic microorganisms: Machine learning and numerical approach
- Machine learning analysis of thermo-bioconvection in a micropolar hybrid nanofluid-filled square cavity with oxytactic microorganisms
- Research and improvement of mechanical properties of cement nanocomposites for well cementing
- Thermal and stability analysis of silver–water nanofluid flow over unsteady stretching sheet under the influence of heat generation/absorption at the boundary
- Cobalt iron oxide-infused silicone nanocomposites: Magnetoactive materials for remote actuation and sensing
- Magnesium-reinforced PMMA composite scaffolds: Synthesis, characterization, and 3D printing via stereolithography
- Bayesian inference-based physics-informed neural network for performance study of hybrid nanofluids
- Numerical simulation of non-Newtonian hybrid nanofluid flow subject to a heterogeneous/homogeneous chemical reaction over a Riga surface
- Enhancing the superhydrophobicity, UV-resistance, and antifungal properties of natural wood surfaces via in situ formation of ZnO, TiO2, and SiO2 particles
- Synthesis and electrochemical characterization of iron oxide/poly(2-methylaniline) nanohybrids for supercapacitor application
- Impacts of double stratification on thermally radiative third-grade nanofluid flow on elongating cylinder with homogeneous/heterogeneous reactions by implementing machine learning approach
- Synthesis of Cu4O3 nanoparticles using pumpkin seed extract: Optimization, antimicrobial, and cytotoxicity studies
- Cationic charge influence on the magnetic response of the Fe3O4–[Me2+ 1−y Me3+ y (OH2)] y+(Co3 2−) y/2·mH2O hydrotalcite system
- Pressure sensing intelligent martial arts short soldier combat protection system based on conjugated polymer nanocomposite materials
- Magnetohydrodynamics heat transfer rate under inclined buoyancy force for nano and dusty fluids: Response surface optimization for the thermal transport
- Fly ash and nano-graphene enhanced stabilization of engine oil-contaminated soils
- Enhancing natural fiber-reinforced biopolymer composites with graphene nanoplatelets: Mechanical, morphological, and thermal properties
- Performance evaluation of dual-scale strengthened co-bonded single-lap joints using carbon nanotubes and Z-pins with ANN
- Computational works of blood flow with dust particles and partially ionized containing tiny particles on a moving wedge: Applications of nanotechnology
- Hybridization of biocomposites with oil palm cellulose nanofibrils/graphene nanoplatelets reinforcement in green epoxy: A study of physical, thermal, mechanical, and morphological properties
- Design and preparation of micro-nano dual-scale particle-reinforced Cu–Al–V alloy: Research on the aluminothermic reduction process
- Spectral quasi-linearization and response optimization on magnetohydrodynamic flow via stenosed artery with hybrid and ternary solid nanoparticles: Support vector machine learning
- Ferrite/curcumin hybrid nanocomposite formulation: Physicochemical characterization, anticancer activity, and apoptotic and cell cycle analyses in skin cancer cells
- Enhanced therapeutic efficacy of Tamoxifen against breast cancer using extra virgin olive oil-based nanoemulsion delivery system
- A titanium oxide- and silver-based hybrid nanofluid flow between two Riga walls that converge and diverge through a machine-learning approach
- Enhancing convective heat transfer mechanisms through the rheological analysis of Casson nanofluid flow towards a stagnation point over an electro-magnetized surface
- Intrinsic self-sensing cementitious composites with hybrid nanofillers exhibiting excellent piezoresistivity
- Research on mechanical properties and sulfate erosion resistance of nano-reinforced coal gangue based geopolymer concrete
- Impact of surface and configurational features of chemically synthesized chains of Ni nanostars on the magnetization reversal process
- Porous sponge-like AsOI/poly(2-aminobenzene-1-thiol) nanocomposite photocathode for hydrogen production from artificial and natural seawater
- Multifaceted insights into WO3 nanoparticle-coupled antibiotics to modulate resistance in enteric pathogens of Houbara bustard birds
- Synthesis of sericin-coated silver nanoparticles and their applications for the anti-bacterial finishing of cotton fabric
- Enhancing chloride resistance of freeze–thaw affected concrete through innovative nanomaterial–polymer hybrid cementitious coating
- Development and performance evaluation of green aluminium metal matrix composites reinforced with graphene nanopowder and marble dust
- Morphological, physical, thermal, and mechanical properties of carbon nanotubes reinforced arrowroot starch composites
- Influence of the graphene oxide nanosheet on tensile behavior and failure characteristics of the cement composites after high-temperature treatment
- Central composite design modeling in optimizing heat transfer rate in the dissipative and reactive dynamics of viscoplastic nanomaterials deploying Joule and heat generation aspects
- Double diffusion of nano-enhanced phase change materials in connected porous channels: A hybrid ISPH-XGBoost approach
- Synergistic impacts of Thompson–Troian slip, Stefan blowing, and nonuniform heat generation on Casson nanofluid dynamics through a porous medium
- Optimization of abrasive water jet machining parameters for basalt fiber/SiO2 nanofiller reinforced composites
- Enhancing aesthetic durability of Zisha teapots via TiO2 nanoparticle surface modification: A study on self-cleaning, antimicrobial, and mechanical properties
- Nanocellulose solution based on iron(iii) sodium tartrate complexes
- Combating multidrug-resistant infections: Gold nanoparticles–chitosan–papain-integrated dual-action nanoplatform for enhanced antibacterial activity
- Novel royal jelly-mediated green synthesis of selenium nanoparticles and their multifunctional biological activities
- Direct bandgap transition for emission in GeSn nanowires
- Synthesis of ZnO nanoparticles with different morphologies using a microwave-based method and their antimicrobial activity
- Numerical investigation of convective heat and mass transfer in a trapezoidal cavity filled with ternary hybrid nanofluid and a central obstacle
- Halloysite nanotube enhanced polyurethane nanocomposites for advanced electroinsulating applications
- Low molar mass ionic liquid’s modified carbon nanotubes and its role in PVDF crystalline stress generation
- Green synthesis of polydopamine-functionalized silver nanoparticles conjugated with Ceftazidime: in silico and experimental approach for combating antibiotic-resistant bacteria and reducing toxicity
- Evaluating the influence of graphene nano powder inclusion on mechanical, vibrational and water absorption behaviour of ramie/abaca hybrid composites
- Dynamic-behavior of Casson-type hybrid nanofluids due to a stretching sheet under the coupled impacts of boundary slip and reaction-diffusion processes
- Influence of polyvinyl alcohol on the physicochemical and self-sensing properties of nano carbon black reinforced cement mortar
- Review Articles
- A comprehensive review on hybrid plasmonic waveguides: Structures, applications, challenges, and future perspectives
- Nanoparticles in low-temperature preservation of biological systems of animal origin
- Fluorescent sulfur quantum dots for environmental monitoring
- Nanoscience systematic review methodology standardization
- Nanotechnology revolutionizing osteosarcoma treatment: Advances in targeted kinase inhibitors
- AFM: An important enabling technology for 2D materials and devices
- Carbon and 2D nanomaterial smart hydrogels for therapeutic applications
- Principles, applications and future prospects in photodegradation systems
- Do gold nanoparticles consistently benefit crop plants under both non-stressed and abiotic stress conditions?
- An updated overview of nanoparticle-induced cardiovascular toxicity
- Arginine as a promising amino acid for functionalized nanosystems: Innovations, challenges, and future directions
- Advancements in the use of cancer nanovaccines: Comprehensive insights with focus on lung and colon cancer
- Membrane-based biomimetic delivery systems for glioblastoma multiforme therapy
- The drug delivery systems based on nanoparticles for spinal cord injury repair
- Green synthesis, biomedical effects, and future trends of Ag/ZnO bimetallic nanoparticles: An update
- Application of magnesium and its compounds in biomaterials for nerve injury repair
- Micro/nanomotors in biomedicine: Construction and applications
- Hydrothermal synthesis of biomass-derived CQDs: Advances and applications
- Research progress in 3D bioprinting of skin: Challenges and opportunities
- Review on bio-selenium nanoparticles: Synthesis, protocols, and applications in biomedical processes
- Gold nanocrystals and nanorods functionalized with protein and polymeric ligands for environmental, energy storage, and diagnostic applications: A review
- An in-depth analysis of rotational and non-rotational piezoelectric energy harvesting beams: A comprehensive review
- Advancements in perovskite/CIGS tandem solar cells: Material synergies, device configurations, and economic viability for sustainable energy
- Deep learning in-depth analysis of crystal graph convolutional neural networks: A new era in materials discovery and its applications
- Review of recent nano TiO2 film coating methods, assessment techniques, and key problems for scaleup
- Antioxidant quantum dots for spinal cord injuries: A review on advancing neuroprotection and regeneration in neurological disorders
- Rise of polycatecholamine ultrathin films: From synthesis to smart applications
- Advancing microencapsulation strategies for bioactive compounds: Enhancing stability, bioavailability, and controlled release in food applications
- Advances in the design and manipulation of self-assembling peptide and protein nanostructures for biomedical applications
- Photocatalytic pervious concrete systems: from classic photocatalysis to luminescent photocatalysis
- Corrigendum
- Corrigendum to “Synthesis and characterization of smart stimuli-responsive herbal drug-encapsulated nanoniosome particles for efficient treatment of breast cancer”
- Special Issue on Advanced Nanomaterials for Carbon Capture, Environment and Utilization for Energy Sustainability - Part III
- Efficiency optimization of quantum dot photovoltaic cell by solar thermophotovoltaic system
- Exploring the diverse nanomaterials employed in dental prosthesis and implant techniques: An overview
- Electrochemical investigation of bismuth-doped anode materials for low‑temperature solid oxide fuel cells with boosted voltage using a DC-DC voltage converter
- Synthesis of HfSe2 and CuHfSe2 crystalline materials using the chemical vapor transport method and their applications in supercapacitor energy storage devices
- Special Issue on Green Nanotechnology and Nano-materials for Environment Sustainability
- Influence of nano-silica and nano-ferrite particles on mechanical and durability of sustainable concrete: A review
- Surfaces and interfaces analysis on different carboxymethylation reaction time of anionic cellulose nanoparticles derived from oil palm biomass
- Processing and effective utilization of lignocellulosic biomass: Nanocellulose, nanolignin, and nanoxylan for wastewater treatment
- Retraction
- Retraction of “Aging assessment of silicone rubber materials under corona discharge accompanied by humidity and UV radiation”
Articles in the same Issue
- Research Articles
- MHD radiative mixed convective flow of a sodium alginate-based hybrid nanofluid over a convectively heated extending sheet with Joule heating
- Experimental study of mortar incorporating nano-magnetite on engineering performance and radiation shielding
- Multicriteria-based optimization and multi-variable non-linear regression analysis of concrete containing blends of nano date palm ash and eggshell powder as cementitious materials
- A promising Ag2S/poly-2-amino-1-mercaptobenzene open-top spherical core–shell nanocomposite for optoelectronic devices: A one-pot technique
- Biogenic synthesized selenium nanoparticles combined chitosan nanoparticles controlled lung cancer growth via ROS generation and mitochondrial damage pathway
- Fabrication of PDMS nano-mold by deposition casting method
- Stimulus-responsive gradient hydrogel micro-actuators fabricated by two-photon polymerization-based 4D printing
- Physical aspects of radiative Carreau nanofluid flow with motile microorganisms movement under yield stress via oblique penetrable wedge
- Effect of polar functional groups on the hydrophobicity of carbon nanotubes-bacterial cellulose nanocomposite
- Review in green synthesis mechanisms, application, and future prospects for Garcinia mangostana L. (mangosteen)-derived nanoparticles
- Entropy generation and heat transfer in nonlinear Buoyancy–driven Darcy–Forchheimer hybrid nanofluids with activation energy
- Green synthesis of silver nanoparticles using Ginkgo biloba seed extract: Evaluation of antioxidant, anticancer, antifungal, and antibacterial activities
- A numerical analysis of heat and mass transfer in water-based hybrid nanofluid flow containing copper and alumina nanoparticles over an extending sheet
- Investigating the behaviour of electro-magneto-hydrodynamic Carreau nanofluid flow with slip effects over a stretching cylinder
- Electrospun thermoplastic polyurethane/nano-Ag-coated clear aligners for the inhibition of Streptococcus mutans and oral biofilm
- Investigation of the optoelectronic properties of a novel polypyrrole-multi-well carbon nanotubes/titanium oxide/aluminum oxide/p-silicon heterojunction
- Novel photothermal magnetic Janus membranes suitable for solar water desalination
- Green synthesis of silver nanoparticles using Ageratum conyzoides for activated carbon compositing to prepare antimicrobial cotton fabric
- Activation energy and Coriolis force impact on three-dimensional dusty nanofluid flow containing gyrotactic microorganisms: Machine learning and numerical approach
- Machine learning analysis of thermo-bioconvection in a micropolar hybrid nanofluid-filled square cavity with oxytactic microorganisms
- Research and improvement of mechanical properties of cement nanocomposites for well cementing
- Thermal and stability analysis of silver–water nanofluid flow over unsteady stretching sheet under the influence of heat generation/absorption at the boundary
- Cobalt iron oxide-infused silicone nanocomposites: Magnetoactive materials for remote actuation and sensing
- Magnesium-reinforced PMMA composite scaffolds: Synthesis, characterization, and 3D printing via stereolithography
- Bayesian inference-based physics-informed neural network for performance study of hybrid nanofluids
- Numerical simulation of non-Newtonian hybrid nanofluid flow subject to a heterogeneous/homogeneous chemical reaction over a Riga surface
- Enhancing the superhydrophobicity, UV-resistance, and antifungal properties of natural wood surfaces via in situ formation of ZnO, TiO2, and SiO2 particles
- Synthesis and electrochemical characterization of iron oxide/poly(2-methylaniline) nanohybrids for supercapacitor application
- Impacts of double stratification on thermally radiative third-grade nanofluid flow on elongating cylinder with homogeneous/heterogeneous reactions by implementing machine learning approach
- Synthesis of Cu4O3 nanoparticles using pumpkin seed extract: Optimization, antimicrobial, and cytotoxicity studies
- Cationic charge influence on the magnetic response of the Fe3O4–[Me2+ 1−y Me3+ y (OH2)] y+(Co3 2−) y/2·mH2O hydrotalcite system
- Pressure sensing intelligent martial arts short soldier combat protection system based on conjugated polymer nanocomposite materials
- Magnetohydrodynamics heat transfer rate under inclined buoyancy force for nano and dusty fluids: Response surface optimization for the thermal transport
- Fly ash and nano-graphene enhanced stabilization of engine oil-contaminated soils
- Enhancing natural fiber-reinforced biopolymer composites with graphene nanoplatelets: Mechanical, morphological, and thermal properties
- Performance evaluation of dual-scale strengthened co-bonded single-lap joints using carbon nanotubes and Z-pins with ANN
- Computational works of blood flow with dust particles and partially ionized containing tiny particles on a moving wedge: Applications of nanotechnology
- Hybridization of biocomposites with oil palm cellulose nanofibrils/graphene nanoplatelets reinforcement in green epoxy: A study of physical, thermal, mechanical, and morphological properties
- Design and preparation of micro-nano dual-scale particle-reinforced Cu–Al–V alloy: Research on the aluminothermic reduction process
- Spectral quasi-linearization and response optimization on magnetohydrodynamic flow via stenosed artery with hybrid and ternary solid nanoparticles: Support vector machine learning
- Ferrite/curcumin hybrid nanocomposite formulation: Physicochemical characterization, anticancer activity, and apoptotic and cell cycle analyses in skin cancer cells
- Enhanced therapeutic efficacy of Tamoxifen against breast cancer using extra virgin olive oil-based nanoemulsion delivery system
- A titanium oxide- and silver-based hybrid nanofluid flow between two Riga walls that converge and diverge through a machine-learning approach
- Enhancing convective heat transfer mechanisms through the rheological analysis of Casson nanofluid flow towards a stagnation point over an electro-magnetized surface
- Intrinsic self-sensing cementitious composites with hybrid nanofillers exhibiting excellent piezoresistivity
- Research on mechanical properties and sulfate erosion resistance of nano-reinforced coal gangue based geopolymer concrete
- Impact of surface and configurational features of chemically synthesized chains of Ni nanostars on the magnetization reversal process
- Porous sponge-like AsOI/poly(2-aminobenzene-1-thiol) nanocomposite photocathode for hydrogen production from artificial and natural seawater
- Multifaceted insights into WO3 nanoparticle-coupled antibiotics to modulate resistance in enteric pathogens of Houbara bustard birds
- Synthesis of sericin-coated silver nanoparticles and their applications for the anti-bacterial finishing of cotton fabric
- Enhancing chloride resistance of freeze–thaw affected concrete through innovative nanomaterial–polymer hybrid cementitious coating
- Development and performance evaluation of green aluminium metal matrix composites reinforced with graphene nanopowder and marble dust
- Morphological, physical, thermal, and mechanical properties of carbon nanotubes reinforced arrowroot starch composites
- Influence of the graphene oxide nanosheet on tensile behavior and failure characteristics of the cement composites after high-temperature treatment
- Central composite design modeling in optimizing heat transfer rate in the dissipative and reactive dynamics of viscoplastic nanomaterials deploying Joule and heat generation aspects
- Double diffusion of nano-enhanced phase change materials in connected porous channels: A hybrid ISPH-XGBoost approach
- Synergistic impacts of Thompson–Troian slip, Stefan blowing, and nonuniform heat generation on Casson nanofluid dynamics through a porous medium
- Optimization of abrasive water jet machining parameters for basalt fiber/SiO2 nanofiller reinforced composites
- Enhancing aesthetic durability of Zisha teapots via TiO2 nanoparticle surface modification: A study on self-cleaning, antimicrobial, and mechanical properties
- Nanocellulose solution based on iron(iii) sodium tartrate complexes
- Combating multidrug-resistant infections: Gold nanoparticles–chitosan–papain-integrated dual-action nanoplatform for enhanced antibacterial activity
- Novel royal jelly-mediated green synthesis of selenium nanoparticles and their multifunctional biological activities
- Direct bandgap transition for emission in GeSn nanowires
- Synthesis of ZnO nanoparticles with different morphologies using a microwave-based method and their antimicrobial activity
- Numerical investigation of convective heat and mass transfer in a trapezoidal cavity filled with ternary hybrid nanofluid and a central obstacle
- Halloysite nanotube enhanced polyurethane nanocomposites for advanced electroinsulating applications
- Low molar mass ionic liquid’s modified carbon nanotubes and its role in PVDF crystalline stress generation
- Green synthesis of polydopamine-functionalized silver nanoparticles conjugated with Ceftazidime: in silico and experimental approach for combating antibiotic-resistant bacteria and reducing toxicity
- Evaluating the influence of graphene nano powder inclusion on mechanical, vibrational and water absorption behaviour of ramie/abaca hybrid composites
- Dynamic-behavior of Casson-type hybrid nanofluids due to a stretching sheet under the coupled impacts of boundary slip and reaction-diffusion processes
- Influence of polyvinyl alcohol on the physicochemical and self-sensing properties of nano carbon black reinforced cement mortar
- Review Articles
- A comprehensive review on hybrid plasmonic waveguides: Structures, applications, challenges, and future perspectives
- Nanoparticles in low-temperature preservation of biological systems of animal origin
- Fluorescent sulfur quantum dots for environmental monitoring
- Nanoscience systematic review methodology standardization
- Nanotechnology revolutionizing osteosarcoma treatment: Advances in targeted kinase inhibitors
- AFM: An important enabling technology for 2D materials and devices
- Carbon and 2D nanomaterial smart hydrogels for therapeutic applications
- Principles, applications and future prospects in photodegradation systems
- Do gold nanoparticles consistently benefit crop plants under both non-stressed and abiotic stress conditions?
- An updated overview of nanoparticle-induced cardiovascular toxicity
- Arginine as a promising amino acid for functionalized nanosystems: Innovations, challenges, and future directions
- Advancements in the use of cancer nanovaccines: Comprehensive insights with focus on lung and colon cancer
- Membrane-based biomimetic delivery systems for glioblastoma multiforme therapy
- The drug delivery systems based on nanoparticles for spinal cord injury repair
- Green synthesis, biomedical effects, and future trends of Ag/ZnO bimetallic nanoparticles: An update
- Application of magnesium and its compounds in biomaterials for nerve injury repair
- Micro/nanomotors in biomedicine: Construction and applications
- Hydrothermal synthesis of biomass-derived CQDs: Advances and applications
- Research progress in 3D bioprinting of skin: Challenges and opportunities
- Review on bio-selenium nanoparticles: Synthesis, protocols, and applications in biomedical processes
- Gold nanocrystals and nanorods functionalized with protein and polymeric ligands for environmental, energy storage, and diagnostic applications: A review
- An in-depth analysis of rotational and non-rotational piezoelectric energy harvesting beams: A comprehensive review
- Advancements in perovskite/CIGS tandem solar cells: Material synergies, device configurations, and economic viability for sustainable energy
- Deep learning in-depth analysis of crystal graph convolutional neural networks: A new era in materials discovery and its applications
- Review of recent nano TiO2 film coating methods, assessment techniques, and key problems for scaleup
- Antioxidant quantum dots for spinal cord injuries: A review on advancing neuroprotection and regeneration in neurological disorders
- Rise of polycatecholamine ultrathin films: From synthesis to smart applications
- Advancing microencapsulation strategies for bioactive compounds: Enhancing stability, bioavailability, and controlled release in food applications
- Advances in the design and manipulation of self-assembling peptide and protein nanostructures for biomedical applications
- Photocatalytic pervious concrete systems: from classic photocatalysis to luminescent photocatalysis
- Corrigendum
- Corrigendum to “Synthesis and characterization of smart stimuli-responsive herbal drug-encapsulated nanoniosome particles for efficient treatment of breast cancer”
- Special Issue on Advanced Nanomaterials for Carbon Capture, Environment and Utilization for Energy Sustainability - Part III
- Efficiency optimization of quantum dot photovoltaic cell by solar thermophotovoltaic system
- Exploring the diverse nanomaterials employed in dental prosthesis and implant techniques: An overview
- Electrochemical investigation of bismuth-doped anode materials for low‑temperature solid oxide fuel cells with boosted voltage using a DC-DC voltage converter
- Synthesis of HfSe2 and CuHfSe2 crystalline materials using the chemical vapor transport method and their applications in supercapacitor energy storage devices
- Special Issue on Green Nanotechnology and Nano-materials for Environment Sustainability
- Influence of nano-silica and nano-ferrite particles on mechanical and durability of sustainable concrete: A review
- Surfaces and interfaces analysis on different carboxymethylation reaction time of anionic cellulose nanoparticles derived from oil palm biomass
- Processing and effective utilization of lignocellulosic biomass: Nanocellulose, nanolignin, and nanoxylan for wastewater treatment
- Retraction
- Retraction of “Aging assessment of silicone rubber materials under corona discharge accompanied by humidity and UV radiation”